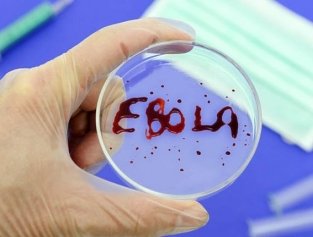
Если Эбола придет в Россию Если Эбола придет в Россию

Новости по тегу "Эбола"
Ассоциация торговой недвижимости и экспертов ритейла
WB Книги
Infinity Lingerie
Level Group
Pyrus
Российская ассоциация аптечных сетей
Comcity
фунчоза
Елена Суворова
MENI
поколение X
медиаплееры
Евразийская алкогольная группа
Ассоциация блогеров и агентств
kilbil
Looton
Xiaomi 17
Гофромир
Стильхаб
North Sails
Bodycore
Demiroff
Металлинвестбанк
Алексей Боев
ПланФакт
Retail TECH Expo
Russian Retail Show
Башспиртпром
Счастливый взгляд
азиатская кухня
GMONIT
BESTUNE
QSOFT
Second Friend Store
Рободоставка
Кордиант
автомобили с пробегом
Никита Терехов
ТЦ MEGANOM
FES retail
финики
Союз электронной торговли
Пензенская область
RetailCRM
индекс предпринимательской уверенности
рамен
ЭКСИ Банк
DOM Лента
стритфуд
VanWok
Воккер
Смотрешка
Geltek
Case 2 Case
электроснегокаты
МТС Юрент
Национальные алкогольные традиции
Александр Петров
Патриаршие пруды
BrandLab
TimePad
ТРЦ Avenue Sever
Ecoplatform
H-Tab
Lindex Group
Хлеб Насущный
аперитивы
Costa Coffee
Федерация независимых профсоюзов России
Ангелина Мельникова
Data-Mall
Реми
Карачаево-Черкесия
Brandt
Galderma Group
Ассоциация предприятий мебельной и деревообрабатывающей отрасли России
Aurus Cashmere
Радио Monte Carlo
FaceTime
брелоки
Выберу.ру
Аяз Шабутдинов
Максим Терешков
Northland
Media Instinct Group
BI.ZONE
умные весы
Ortiga Developmen
Yagoda
Ozon Фармацевтика
ТЦ Максимир
Ассоциация мерчандайзинговых агентств
Займер
BHV
галантерея
Воркута
Ухта
Республика Коми
ROSSKO
FIT SERVICE
Первым делом
Союз интернет-торговли
Центрпродсервис
Swank
Нетто
Munchery
приостановка деятельности
ТЦ Алтын
Austin Reed
Adobe
Космостория
УК Велес менеджмент
ГК Пионер
X5
тыква
Бустрейд
LAMACON
ГК Талина
Сбербанк Инвестиции
Не просто вещь
Самолет
влажные салфетки
CONTE
Ещё
День народного единства
Яндекс Ритм
Петербургский дизайн
e-legion
HEALBE
Николаевский
PUNKT E
Ассоциация облачно-ориентированных технологий
VK Cloud
7-Eleven
сеть Smart
LED-экраны
программирование
UzPost
Renaissance Development
SELA HOME
шринкфляция
винная карта
Рубрик
Алцея
МЕГА Екатеринбург
Юнифрост
Amazing red
Место встречи Патриот
грейсторы
Логика молока
Капля молока
социальная коммерция
Nice & Easy
Makita
Madame Coco
Pelican
World Food Moscow
RWB Media
F6
Whitebird
Хлебник
оцифровка
The Бык
Аркадий Юрлов
ТЦ Город Лефортово
Cats&Dogs
Алексей Комков
Mirinda
PNK Северное Шереметьево
Избёнка
iPhone 17
аниме
Союз автомобильных дилеров
Hmarket
китайские автомобили
Елисей Долгих2
отключение интернета
Sибирская коллекция
Михаил Шуфутинский
контрактное производство
DIAMANT
Dreame
Алла Пугчева
застройщики
новостройки
IDIkea
Кейт Бланшетт
LUUK
Игорь Бронников
Саудовская Аравия
Заряд от Магнита
Дмитрий Груздев
Денис Сахаров
IKON Development
Alphabet
Михаил Белобородов
GRASS
Сергей Есенин
Георгий Горшков
Fabergé
X5 Tech
Noon
Яндекс Роботикс
Андрей Зубрийчук
FinTech Awards Russia
Predicta
редомиляция
ОТП Банк
МТС Adtech
EasyBulky
Тульский пищевой комбинат
Алюминиевая Ассоциация
JAC
MAX
Лабубу
Pop Mart
Stefano Ricci
Del Monte
GUESS JEANS
VK Музыка
Viqeo
Steam Deck
Ресейл Маркет
цифровой помощник
Ассоциация представителей электронной торговли
MAR Consult
Aurus
плавучий дом
вареники
DESEO
Место встречи Родина
Team Yandex
сомелье
В1 – Первый выбор
GigaChat
NTech
Hochland
ГК НЕВА МИЛК
Changan
Balance Coffee
Ассоциация книгораспространителей
Quick Resto
шаурма
Ассоциация канцелярского рынка
Гжельский фарфоровый завод
Кировская меховая фабрика
Федор Конюхов
Хейли Бибер
Т-Технологии
Северный Кавказ
ОМПК
Петровские деликатесы
Бахрейн
Магазинус
Магазинас
FUNDAY
ВБ Девелопмент
цикорий
Марина Малахатько
Logistika Expo
ГК Стилобат
Митпром
холодный чай
Ceconomy
Кисловодск
Indeepa
Adventum
Анастасия Родина
Rolex
правильное питание
Roots
горчица
Екатерина Ярина
OpenAI
Wibes
автокафе
Вологодская область
Российский аукционный дом
BPMSoft
ICL Soft
Mashad Leather
Ритейл стори
Ceetrus
ТАВРОС
Shacman
Александр Овечкин
Диля Хасанова
Ассоциация производителей и поставщиков готовой еды
веганская продукция
Александр Паль
Barilla
ТРЦ Марко Молл
апсайклинг
Татьяна Навка
Сергей Жуков
Вагит Алекперов
Александр Сарычев
Евгения Медведева
Genshin Impact
Южная Осетия
Капитал Инвест
Webbankir
ECOM Expo
HOUSEWARE EXPO
RUSSIAN TRADE EXPO
Апраксин двор
Retail Media
Юлия Лазарева
ECOM Expo'25
Елисей Долгих
Shaman
Константин Ивлев
Анна Сорокина
самозапрет
Елена Блиновская
Татьяна Ким
Гжельский Фарфор
EW-Club
ГИБДД
Гондурас
Mobisharks
АЭД
Kappa
ТРЦ Happy Молл
ATHLEX
ТРЦ BOTANICA
Bloomberg
Блюмарт
DeepSeek
ViAi Lab
Кувейт
FACE CODE
ГК Гранель
Три цены
Baggins Coffee
DigiTaxFree
Catrinix
ТЦ Савёловский
X5 Media
Спецпроект
Денис Чекрыгин
Huajing
Xandres
Хлебница
ЕГРН
Invest7
Бери заряд!
ABBYY
ProstoKap
Конкурс Кейсов
ТРЦ Алания Молл
ТЦ Green City
Контур.Толк
Ticketscloud
Александр Гришак
Алкогольная производственная компания
Getblogger
ингаляторы
Мясная лавка
Pruffme
Дмитрий Гнилица
Илья Куснирович
Retail Skills
ОИРОМ
недобросовестные потребительские практики
Мосстат
Brick Labs
ВкусВилл Красиво
OVS
Fiba Retail Group
МГКЛ
цифровые финансовые активы
Jaguar Land Rover
Hirestreet
конструктор
Можайский кондитерский дом
RBT
Первая мебельная фабрика
Hobby World
Jacob & Co
Invisible
Мария Григорьева
Cube.Moscow
Asia st 71
Team Talk
t2
Nikasport
STARWIND
Яндекс Фабрика
IBC Global
Евгения Кузьминых
Action
Домком
Health&Nutrition
Главпродукт
SUPPLEMENT GROUP
Домовой
Ламбумиз
VK Реклама
T-Bank
трудовые мигранты
CeMAT
НАУРР
Авито Финанс
Тверская область
Магаданская область
MAY24
Hazzys
COMITAS
Адлер
Арктика
Nebius
Московский Картофель
Русмаркет
Гудвилл
ТРЦ Крекшино
iPhone 16
Евразия
Ценозавр
Nesquik
Nikita Efremov
ЭвоКом
Тантана
Bookmate
YOLLO
Александр Рогов
Восточный экономический форум
Строй Гранд
Ultimo Fashion Group
Ставропольский край
Ессентуки
аудиокассеты
NanduQ
Notion
Владислав Бакальчук
UNOde50
Zimaletto
Okkam
Т-банк
Redmond
иноагенты
Сергей Черненко
Silver spoon
ГК Агропромкомплектация
Малайзия
постоплата
допродажи
CHOUX
Алла Рауд
Глеб Ястребков
опровержение
Victoria Andreyanova
Сергей Кротков
Максим Котенков
НОНТОН
Гастропорт
Лемана ПРО
Екатерина Варжунтович
ТРЦ LeoMall
Анна Холод
HEA
телемагазин
Купер
Роман Чекушов
Первый ОФД
Еврейская автономная область
ТРЦ ОДИПАРК
Oks Labs
Леонид Чуриков
Soueast
Knauf
Toystore
ТЦ MARi
ТД Балтийский берег
Саратовская область
Lada Iskra
ТРЦ Алатырь
STOLNIK
Coffee Machine
Easy Cоmmerce
ITSIBERIA
Suborbia
Звук Бизнес
BULMER
Ассоциация Объединение мясопереработчиков
ТЦ Мой Молл
E-Promo Group
Дэвид Бекхэм
МЕГА Казань
Артём Савиновский
Yadro
Kvadra
Сергей Малышев
Ржев
Антон Алиханов
Ready! Steady! Go!
Абрау-Дюрсо
eNPS
Gallup International
Biletix
Assist
Movinga
Катерина Грог
Кирилл Кулаков
Консоль.Про
маргарин
Валаамские продукты
Profpoint
Wanta Group
Welhome
Barneys
Ted Bakers
KaDeWe
Сбер Бизнес Софт
Надежда Курбатова
Mugler
Русская Школа Управления
Корпорация Центр
Оренбургская область
self-storage
Fashion Factory School
Московская пивоваренная компания
Восток инвестиции
Ante Kovac
Росалкогольтабакконтроль
TCL
Обед.ру
Милош Бикович
NATMALL
Eleventy
Ellassay
IBC Real Estate
минтай
АУРЭК
ТРЦ Кузьминки Молл
мармелад
Румелко
Lynks Property Management
резюме
Advertising Standards Authority
Михаил Сливинский
Нейростат
КЛВЗ
MosHome
MosFit
Милти
Currys
Афанасий
IP-телефония
СберАналитика
Дом Фарфора
Ideco
First in Space
MUNZ GROUP
Рослесинфорг
Cвердловская область
Андрей Постников
М.Мастер
CHARMSTORE
Магнит Маркет
TaylorMade
Vizio
Яндекс Банк
Содружество производственников ЦEХ
CheckOffice
VIRIDIAN
Хлебпром
Haval
Шокирующие прогнозы
PNK Парк Домодедово 2
AGR Automotive Group
МЕГА Омск
Объединенные Пивоварни – Холдинг
Dream Job
Союзтелеком
Юнирест
Cyberspace
Инфосистемы Джет
смена названия
Первая помощь
Lisa Beauty
BoxBot
Bringly
Main Transport
Data.ai
Шедеврум
Kandinsky
Joi Izakaya
Smart Ranking
сервисное обслуживание
Ultimate Education
International Paper
ГК Илим
офисная бумага
прослеживаемость товаров
Novabev Group
редомициляция
Хайдженик
Невская Косметика
Elena Furs
Royal Greenland
Агама
наркотики
Эквадор
Courvoisier
Campari
Дмитрий Хомутов
Chakra
Panier des Sens
ФрешФрост
1001 Платье
ТРЦ Жемчужная Плаза (Cанкт-Петербург)
ТРЦ Каширская Плаза (Москва)
ТРЦ Реутов Парк
ТРЦ Галерея Краснодар
Союз органического земледелия
Киевский метрополитен
МегаЛабс
ТРК Москворечье (Москва)
Петербургский метрополитен
Казанский метрополитен
БЦ RiverDale (Москва)
Титан-Девелопмент
ТЦ Измайловский
продуктовый ритейл
Питер Партма
A&NN Retail
M1 Solutions
ТРЦ Галактика (Смоленск)
Eлец
ЕвроГрупп
Финстрой
Alto Assets
DVI Group
ТЦ Алтай
IDOL
ТРК Международный (Санкт-Петербург)
ТРК 5 Озер (Санкт-Петербург)
Выборг
ТРК ЛЕТО (Санкт-Петербург)
ТЦ Манго (Одинцово)
ТРК Маяк (Дубна)
ТРЦ Ultra City Mall (Уфа)
ТРК Сквер
Berhasm
Agatha
APM Monaco
Balabala
Semir
Focus Technologies
ТЦ Времена Года
Кондитерская группа Лесная сказка
российская полка
Green
BLCV
корпоративы
Да дому
Absolut POS
Free Lines Company
Ассоциация цифровых платформ
крабовые палочки
Zotman
Carte Noire
build-to-suit
Сделано в Москве
Pergaev Bureau
Оборот.ру
Иван Кургузов
ТЦ Новоарбатский
ТРЦ Любимово Молл
Desport
Ketroy
OMNI RATING AWARD 2023
Евразийская неделя маркетинга
GIGA CHAT
YaGPT
ГК Солар
кашемир
развивающие игры
Харди Гарди
китайские товары
Победа
эксклюзивные торговые марки
Астана
Танк & Хоппер
билайн adtech
Олово
Бронницкий ювелир
геосервисы
Курская область
Эфиопия
iPhone 15
Анна Родина
К2Тех
Алексей Загайнов
YULIAWAVE
Кавказ
Галина Кравченко
DALL-E
Евгения Казакова
ГК Mainsgroup
Mains
Павел Озеров
ЦОД
Крокус Экспо
Goldben
Хай Иен Нгуен
Большая птица
CloudShop
Антисклад
LiteBox
SUBTOTAL
Shiptor
Андрей Касалинский
Naf Naf
Московский постомат
Simon-Kucher & Partners
РТК-Солар
GeoPost
Екатерина Гаврина
мастермайнд
Екатерина Дегтяренко
Андрей Губанов
Дмитрий Серёгин
Денис Колокольников
Анна Лапада
Сергей Митрофанов
Webim
Самвел Арутюнян
Александр Штеренлихт
SwissPharm
Бланк
Екатерина Борщева
SUP-борд
ВоблаBeer
Headline
Никита Шистеров
Катар
Степан Гаврилов
Умные парковки
Андрей Колодич
CRE+Retail group
Наталия Кермедчиева
аудиобейдж
Speechmate
Олег Рогожин
Roark Capital
холодовая цепь
Обонато
Евгений Глухоедов
Kiton
Lucky Bear
матчинг
Vicuna
Эдуард Ашрафьян
Галина Коротун
Александра Галкина
Лариса Зеленкова
Медак фарма
транспортные компании
Delko
Санджар Ашуралиев
Модуль
Александр Альтшуллер
КСЭ
Галина Кезикова
Эдуард Миронов
Инна Калинина
Новосибирский завод бытовой химии
Мокка
red_mad_robot
Dialog X5
Дария Чапалда
Игорь Епанешников
Domus
Comunica
Объединенная чайная компания
Антарес Вижн Россия
Павел Булгаков
JVO
Максим Логинов
Cергей Молчанов
Валерия Зелинская
Максим Бухаров
SellMonitor
FCPROJECT
ZILOTI
Диджитал медиа холдинг
Opticell
Мария Горобец
YOU WANNA
Van Cleef
Graff
Bvlgari
Kismet Capital Group
Максим Чехович
Ventra Trade
окрошка
Мармакс
Mono-Stil
Monza
Елена Мельник
Дарья Ли
Ренессанс страхование
барбикор
Capri
Tapestry
Rovio
Sega
X5 Клуб
ТЦ ОБНИМИ (Обнинск)
Дрова
Ёлки-Палки
Патио Пицца
TSM Agency
Алина Абдулова
Трейд Менеджмент
Игорь Григораш
Автотор
увлажнители
Ярославский бройлер
Демид Голиков
Viva La Vika
Minimo
Ксения Лисьева
Александр Авдеев
Вячеслав Козин
Japan Industrial Partners
контрагенты
Псковская область
СКАН-Интерфакс
Гузелия Имаева
А4Group
Fiba Group
Vestel
VERSO
YCH
EENK
ANTA
New Balance
буккросинг
Similarweb
спуфинг
Тендерплан
Академии тендерных продаж
Марина Власенко
РОАД
Brand Pulse
JOUR
Picard
Delitraiteur
Jumbo Foodmarkt
Uppetit
Антон Дулов
цифровой рубль
Олег Пестерев
SYNERGETIC
Мегамаркет
Вязьма
Portobello
Лидия Осипова
Аркадий Пасенко
Gamma Invest Group
Orion Group
НОНТОН.РФ
Любимая кухня
Григорий Акулов
JUST CLOTHES
PR
Елена Малышева
ТЦ Гранд-Марина (Сочи)
СК-Трейдинг
ТРЦ Тау Галерея (Саратов)
Diamonds are Forever
Галина Язова
Владимир Язов
Альпина Паблишер
Дмитрий Норка
Market Papa
F.A.C.C.T.
Кибердом
Сергей Калмыков
GoodHelper
Lucky Skills School
Ultima Яндекс Еда
«Путина»
Hisense
Алена Тихова
PayKeeper
Unitpay
PayAnyWay
WalletOne
Марианна Скворцова
Станислав Смирнов
Алина Сибгатуллина
Sellty
Кристина Барзаковская
Моремания
LAB Industries
Мультикубик
коммунальная авария
Ночь арендатора
Российский союз кожевников и обувщиков
Temu
Xpeng Motors
Nio
BYD
Сергей Молчанов
Опт Юнион
Иван Новиков
Евгений Сахаров
Vertical Aerospace
DEHA
бутилированная вода
Нью-Йоркская фондовая биржа
Ushiqlo
Ивановская текстильная компания
Татьяна Громова
Lavazza
McCain
Lamb Weston
Андрей Кутузов
Алексей Качурин
Яна Постнова
Williams Oliver
THE CULTT
Пыжикофф
Альпина PRO
Яна Лукашева
Maro Candle
VI-media
Илья Варлахов
Юлия Блинова
Creed
СМО Unidragon
HFLabs
Тимур Сафиуллин
ТРЦ Сургут Сити Молл
Маркет 15
Dinex
Mentos
мультимерчант
Ашот Григорян
Андрей Шляев
Tinkoff eCommerce
Мария Пономаренко
Алексей Шемякин
Green Crab
WEE
Emka
Евгений Сазонов
Передовые Платежные Решения
Любимый
Дарья Антюфеева
Gallery
Russ Outdoor
Сварог
MCosmetic
Малышам
ФрутоKids
Липецкий бювет
inni
ТЦ Ясенево
индустрия гостеприимства
Базис
Анастасия Планидина
Белоруссия
МаркетПапа
Никита Горностаев
Apple Music
Cubic Music
Дмитрий Яковлев
Лада Булавицкая
Галерея Мебели
GTLogistics
Иван Денисов
Валентин Шаталов
MAGNUM
Bosideng
Erdos
IWC
Decorté
Shiseido
Pola
Fancl
Clé de Peau Beauté
SK-II
Владимир Мельников
Гуд Лакк
Lassie
Reima
Ccilu
Rens
Soludos
Vegea
Le Coq Sportif
Zèta Shoes
Юлия Русинова
Михаил Зотов
Е.Кампани
VÄRD
Wolta
Евгений Непейвода
биржа смен
New Retail Forum
Eterna
Retail Story
обратный опцион
Mercedes-Benz
Lex Borealis
Михаил Мурадов
YOU
МТС RED
Lee Cooper
фискализация
Сусанна Ураева
Indrive
Б-152
Никита Володин
Гордей Алексеев
открытие офиса
покупка производства
Fashoin прокачка
МилФудс
Kelebek
Big Smile Coffee
Светлана Сипарова
Андрей Сериков
Елена Селиванова
Таисия Голубева
Ирина Питерсон
Полина Упитис
uForce
Commo
TopFranchise.ru
ROWI
Chloe
Evocargo
PIM-система
Евгений Егоров
Compo Platform
Globus IT
MidJourneу
Progressive Media
Андрей Курилович
Надежда Плечкова
Direct Service
Елена Евсевлеева
Sherpa RPA
Константин Артемьев
пищевое производство
Антон Луцевич
Salary Index
Екатерина Ивашкевич
Мария Бакатова
Екатерина Фунтинкова
Лаборатория права
Антон Ивлев
Маркет Деливери
Дмитрий Колесников
ЭКФ
ГК Прайд
ТМК tools
Norbel
Norgau
Garwin
Мир инструмента
Галацентр
Максмарт
Инна Матчина
Multicold
АНО Цифровая экономика
Сергей Гребенников
WhatsApp Business API
Добрынинский
Ctrlweb
Николай Резун
ГК Renton Yard
Дарина Солодкова
упакованная вода
Directum RX
Megs Menopause
Vichy Neovadiol
Kaja
TooFaced
Odeuropa
Mutha
By Beauty Bay
Comfort Zone
бьюти
Дмитрий Ставицкий
Алиса Ермакова
самовыкуп
Александр Ежов
Союзмульткафе
золото
Moneygold
GOOD VOLT
Kurnik Group
Ростелеком-ЦОД
Umbrella IT
Константин Попандопуло
бренд-медиа
Юлия Питка
LC Waikiki
Mavi
Денис Нуждин
АО ПРОГРЕСС
Анна Алхимова
Виталий Теин
ТЦ Тройка
YandexGPT
Poetti
ТехноСпарк
Ronavi Robotics
Иван Бородин
техподдержка
Inssmart
Артур Коломиец
Халва Экспресс
Imperator Forum 2023
бизнес-премии
Collabrom Awards
Ольга Деденко
Юлия Волощук
робот-курьер
ТЦ Южный
DIY&Household Retail Russia 2023
Андрей Лисица
Полина Величкина
Всемирная организация винного туризма
Brandly
бизнес
Мария Азаренок
Мята
Hurma Recruitment
Екатерина Стародубцева-Калачева
TYMY
Алексей Майстренко
ЛЭТУАЛЬ
Мария Михайлова
форматы в ритейле
Анастасия Любарская
Полина Минеева
Всёгазин
Артекс
Галерея самоцветов
Градусы
PRECISE
товары для пожаротушения
бизнес-аккаунт
рассылки
Pigeon
VediTа
CafeStore
Александр Казеннов
Анастасия Чертовских
PanClub
Гоша Рубчинский
MATÜ
WHY NOT?
Полина Рудакова
Русский рыбный мир
MUDO
Мстислав Воскресенский
Александр Шуркаев
Марина Фролова
Sellematics
Директфуд
реестр стартапов
Автотека
Московская неделя моды
Светлана Пермякова
Канцпарк
Михаил Цапок
Виолетта Булгакова
Марина Филиппова
маркетинговые инструменты
Вкусная жизнь
Hema
Epinduo
Tendam
Women’secret
Сергей Илюха
Василий Тарасевич
Rookee
Qlever Solutions
Андрей Харлак
Гватемала
Эля Халили
Jaecoo
DUB
Даурен Абеуов
Мария Литвинова
Виктория Карташова
Союзфарма
UMIDIGI
Павел Шиляев
Lazurit Мебель
Анастасия Рогачева
Collabroom
Frank RG
Ирина Ратина
Singha
Krombacher
Clausthaler
Budweiser
Hofbräu
Александр Ромашин
Hobby Games
настольные игры
BRandICE
Денис Смелов
Анна Старкова
Иван Иванов
Илья Губарев
TimeTrial
CDEK.MARKET
YallaMarket
Komod
Александр Гладков
Мария Третьякова
управление рабочим временем
Шаталов Роман
кофейный рынок
The Welder Catherine
Анастасия Филиппова
Минск
ChatGPT
Игорь Прокудин
Replay
Мобиус Технологии
Николай Молчанов
Иван Крутько
Елена Шкирдова
Михаил Замыцкий
MAAG
Сергей Жданович
Игорь Зеленько
Leader Team
Retail Services
PrestaShop
UPM
Альфа Хим Групп
селедка
SobMaExpo
Бизнес-Квартира
Виктор Соловьев
Now
Дзен
Денис Волков
Екатерина Ньюман
Lemon.online
Марина Кашина
Юрий Богданов
ГамаВетФарм
РАСТИ
Олег Шевелев
Hotfix
Евгений Слиняков
Marketing Division
Инга Вахитова
Сергей Старцев
MALLPIC SOCHI
Бейонсе
ТВК Калина Молл
Nokian Tyres
Инвест Плюс
First Citizens Bank
Silicon Valley Bank
Sapato.ru
Shopbop
MultiShip
Градус
Слотекс
СберМаркетинг
Лузалес
Всемирная федерация ассоциаций прямых продаж
LORUS SCM
Marc Cain
ECE Russland
Midjorney
FM-услуги
Логопарк Шушары
Никита Цой
High
ТРЦ Европейский (Москва)
текила
Татспиртпром
Даниил Прохоров
сегментация
клиентская база
Мара Склярова
Тандер
ГК Белая Долина
Альбина Искакова
Екатерина Мезенцева
HRlink
Дмитрий Махлин
Фармаимпекс
Vianor
Ivanor
Zebra Toys
Андрей Тарабурин
Алексей Гевлич
Антон Сиземин
ВсеАптеки
UPGRADE RETAIL Весна 2023
АстМаркет
ГК Аметист Групп
Наймикс
Виктор Емец
Карина Гудова
Central Properties
Logicor
Марина Холодник
Ассоциация компаний индивидуального хранения
S8 Capital
Добропек
Олег Стерлядев
EMAILMATRIX
Лиана Галина
травяные напитки
KarlLagerfeldJeans
Hugo
CalvinKleinJeans
ConceptGroup
Осьминожка
Денис Нагаев
Михаил Шрайбман
Мясная мануфактура Лыткарино
бижутерия
Club
Coffee Like
Funko Pop
Икорный
WTM Establishment
Eastnine
Мэри Кэй
Рут Хэндлер
Ingenious Designs
Miracle Mop
Джой Мангано
CHiQ
Toblerone
Midjourney
Константин Локтев
RamaYoga
Олег Свечкин
CберМаркетинг
ПиццаФабрика
Суши Wok
Антон Порхунов
MetaShip
термобелье
SoBeautiful
Фабрика еды
izipoint
Food Miles
STUDIO 29
Hepsiburada
Jumia
Mercado Libre
Romb
Околоритейл
Дамир Губейдулин
Василина Гутьеррес
Swed House
NetWork
Спортмастер медиа
Ирина Исмаилова
Volt Energy
Бирюса
Проект 111
Buzzoola
AdTech
Банана- мама
Рамстор
Патэрсон
Сергей Фомин
General Catalyst
InDriver
чек коррекции
Ассоциации экспертов безопасности ритейла
Константин Сергеев
Linux
GetGo
Bing
Scandipakk
Looper Textile
Good Food
Дмитрий Сизон
Unisender Go
Popcorn Books
Hype Expert
Атлуханов Руслан
Тимур Марусяк
Viatris
Motherbear
EXEED
OMODA
Delta Системы
Альтернативные системы
Андрей Мусинов
Наталья Нечаева
CMWP
ТехноСтрой
Cobrazz
Genius Group
Геннадий Нагорнов
Денис Савельев
Грошев Святослав
Безматерных Ольга
Ивлев Константин
Каприелова Светлана
Ефанова Виктория
TexTerra
Аркадий Пекаревский
Борис Остроброд
БРПИ
Валента Фарм
Ксения Гладкова
Владимир Петров
Йола-маркет
Рамиль Нигмадзянов
СуперМаг Плюс
Сервис Плюс
Ритейл Софт
Maskking Technology
The Blueprint
Михаил Синёв
Андрей Гречкин
Дальрефтранс
АСОРПС
Ольга Тарасова
SNS
даунсайзинг
Media Direction Group
Алена Разбирина
кассовый разрыв
Paul Smith
Franca
IDEA
Voli
HDL
Черногория
Мария Голенкова
MOSSA Jewelry
Мария Кингсли
Isakov Jewelry
Виктор Исаков
ЮВЕТОН
Веста Астапович
ProductHub
Евгений Паршин
RETAIL TECH 2023
NITC
MAXMA.com
Chat GPT
Семён Пименов
Ирина Шанина
ELEGANZZA
Fashion House Group
SneakerBox
ГЕРОФАРМ
Sanofi
Росатом
Kept
Б1
Changellenge >>
Ingenico
Котофей
Астраханская область
рабочие места
Smart Engines
Владимир Арлазаров
ББР Банк
Александр Петровский
Электронные деньги
Виктор Достов
Алексей Благирев
Пурпур
Елена Захарова
Deserved.ru
Эрик Шеховцев
Kinky Company
Таисия Решетникова
Приморский край
ZoneSmart
MasterTMS
Performance Business Director
Андрей Недосекин
Daher Group
BOOTWOOD
Вардан Варданян
классифайды
Фили-Бейкер
uber-платформы
AceTarget
Антон Кладов
CDEK Pay
Westland
перемаркировка
Артемий Терехов
Чебурашка
mallpic
Румлес
Е2Е4
Ренна
i2crm
Винни
GATE31
Phluid Project
Boy Smells
унисекс
Банк еды Русь
ЦСП Платформа
Алексей Фирсов
Владислав Головкин
Павел Слав
Charged Retail
Floris
Илья Пуйда
Михаил Волков
Сергей Котик
Bentley
ТРЦ Сибирский молл (Новосибирск)
MD Facility Management
Сгоряча
Markway
Милена Худякова
Foxconn
Иван Гомонов
kuvalda.ru
Михаил Мятов
Борис Бобровников
LAU QUAN
Ijvan
Котани Рус
Цимлянские вина
сити-парк Град
Jones Road
Консул
промопродукция
ICONICOLOR
Михаил Кузнецов
Bosco di Ciliegi
Queue Buster
Павел Голуб
Dr.Petzer
Homzen
Light Bites
Harty
Carnica
Delisse
Почтовая марка
Hola
Junion
Eat no meat
KuMiHo
Moriki Doriki
SODA
DOLCE MILK
Domfy
Tuvio
Get experts
Винный гид
ТРЦ Парус
Бари Алибасов
Ace Target
Инна Дементьева
Екатерина Анциферова
Rostic’s
Robert Mondavi
Snapple
Екатерина Фуголь
Елена Бондарчук
Чайная ложка
Pro Контент
Аня Галашева
Юля Гулюк
Наталия Чижова
Hiker
уберизация
Soho Fashion Group
Яхно и партнёры
RС POS
RC Group
Роман Фомин
марципан
Хлеб и соль
Михаил Парамонов
ПромоСтраницы
SMM Ingate
Екатерина Лаврова
Рецепты бабушки Агафьи
iWENGO MARKET
Юлиана Гордон
Фёдор Вирин
bugmd.com
Дарья Клокова
DHL Logistics Trend Radar
МИРТЕК
Вита Джус
WARPOINT
Divan.ru
YouTravel.me
Mario Berlucci
Monro
NICE ONE
Элиза Али
ГОТЭК
Mondi
Фёдор Сокирянский
готовая еда
Kellogg's
судебный иск
ТОМАТО
Анастасия Кленкина
Ярослав Твердов
Росимущество
монобрендовые магазины
Игорь Щедрин
управление заказами
OMS-системы
Starfish 24
Роман Давидов
Меркатус
Лео Шевченко
Хлебный дом
Эсперанс
календари
СтройТракт
ТЦ Стройпарк
Дмитрий Азаров
Орловская область
Pandao
Анастасия Кожевина
Брюссель
Логистика – и точка
Александр Герасимов
Наталия Котова
Яшкино
Простоквашино
SMS Aero
Константин Сажин
ресейл
LOOKY
Бочкари
Станислав Коротецкий
Trivago
Tinder
Лидия Гончарова
Oomph
ТРЦ Сказка
Белград
Relocata
USEDESK
Squall
Андре-Пьер Буздум
Илья Сергеенко
Арсений Даббах
Сергей Будяков
Павел Семенов
деликатесы
Дмитрий Ермолаев
ТРЦ Изумрудный город (Томск)
Добрыня
ТРЦ ВиВа!
ТЦ Статус (Королёв)
Роман Абрамович
Варвара Забродина
Григорий Яффа
Пан Чемодан
Наталия Софронова
ЭТрН
минимальные розничные цены
Дмитрий Саутенков
Эго Технологии
Emodika
Williams Et Oliver
Екатерина Пантелеева
Александр Чухонцев
Игорь Боженко
сборщик заказов
Георгий Иващенко
La Maison Simons
Y2
mallexpert
sca.rbk
Тодасё
раздел бизнеса
ТРЦ Мозаика (Москва)
цифровые двойники
ТЦ Елоховский пассаж
зима
Fair Isle
Алкогольная сибирская группа
Olam International
Lalibela Coffee
НАПИ
Место встречи Киргизия
Колеса даром
Александр Афанасьев
Тамара Машницкая
Demix
Татьяна Иванова
Hotjar
веб-аналитика
KISLOROD
Максим Жуков
Мария Курдина
Дм-тех
Дмитрий Бахтин
Krispy Kreme
Союз производителей иван-чая
ЛАНИТ
Норбит
Денис Смирнов
KEDDO
Smena
Ассоциация Международной Экономической Стратегии
Александр Дворский
Амиран Ибрагимов
Inventor Soft
Retail Business Russia
Quattrocomforto
Pulse
Instreet
Ольга Швенк
Дмитрий Кармишин
Фродекс
Максим Каминский
авторынок
Московский Постамат
Сергей Хитров
Кристина Спирёва
KANZLER
Монголия
Balenciaga
Urban Vibes
Сюрвеер
Константин Красовский
Николай Гальянов
корм для животных
Kuzminki Mall
Артем Богданов
Dr Pepper
Burn
Владислав Пономарев
Ольга Бузова
Му-Му
Retair
Максим Матвеев
Vnukovo Outlet Village
Juicero
ТРЦ Мармелад
ООО Супер
ООО Кани
MarketGuru
Максим Гральник
iFellow
Илья Парамонов
Алексей Ильин
Алексей Милькин
Fortenova Group
Мелодия здоровья
Everest
Key Account Manager
Velkopopovický Kozel
Stella Artois
Hoegaarden
Солнце Москвы
гастрокластер
Jägermeister
Gulliver Toys
Button Blue
Gulliver Group
Gulliver Market
RevGames
Антон Данюшин
СМП
Text.ru
Галина Соколова
Место встречи Будапешт
Bridgestone
Тинькофф Авто
Napoleon IT
Руслан Ахтямов
Денис Гасилин
Twist
Machka
Ipekyol
TBDteam
Наталья Романова
бу вещи
Salist
Максим Колесов
INOI
Автодом
грузовики
вещи на заказ
Максим Генке
Havas
Korzinka
Makro
Андрей Сафронюк
Канье Уэст
Сегежа Групп
банковские вклады
Организация бизнеса в других странах
Talantix
Альтерра
Роман Трефилов
Яна Пережогина
Эколь
Башкирская содовая компания
Didenok Team
VR Transpoint
пшеница
Агросила
ГК Дело
Арктическая вода
Telegram Ingate
Алексей Демченко
5D-принтеры
Национальная лотерея
Zemskiy Group
Swedish Match
Orion Pharma
Ассоциация владельцев кинотеатров
Кенгуру
Бухта Юг
FOODCODE
Dr. Bakers
Упсала-Цирк
Кассандра Фадеева
военное обмундирование
Юникосметик
Леонид Немцов
HERES LEGAL
Валентин Бородин
Крымский мост
карта Troy
Слепая курица
Тутанхамон
Чистая вода
Коник
Акваарт
E1
Азбука Качества
Элит Групп
КРАТОН
Киприно
маркировка рекламы
Место встречи Байконур
Юлия Рогачева
Yamaguchi
Meituan Waimai
Amazon Fresh
Delivery Hero
Rappi
программные продукты
Росфинмониторинг
Море трафика
Александр Горбачёв
Оксана Платонова
НАМИ
срок годности
Just AI
Ксения Перова
Лента Онлайн
Lamel
Veldskoen
Виктор Иванов
Newlogic.ai
Михаил Денисов
Русбио
особая экономическая зона
Вячеслав Предыбайло
QR`ME
Kuppersberg
Sovcombank Team Challenge 2022
Java
NF Group
ЮBusiness
Русский букет
Суточно.ру
Ирина Буренко
товарные запасы
КОРУС | Управление запасами
Новатор
TAKE AWAY
МАВТ-Винотека
НОУ-ХАУ
ДОМ-Лаверна
Череповец
Мосигра
СТД СТРОЙУДАЧА
FamilyMart
Алтайский край
Подмосковный фермер
ТРЦ Галерея Новосибирск
ТЦ ГоркиПарк (Казань)
Благовещенск
ТРК CUBUS
Гатчина
ТЦ Западный (Подольск)
ТРЦ Алмаз (Челябинск)
ТРЦ Дружба (Владивосток)
ТРЦ Победа Плаза (Саратов)
SHU
WOS
Полина Пахомова
Фуршет
токен
Isuzu Motors
отечественное ПО
Simtech Development
Олег Бидзан
Ольга Сгибнева
Александр Лукин
Елена Белоусова
Сергей Плешаков
Антон Смирнов
Ольга Лунгул
Андрей Рябинин
Мария Провоторова
Павел Маликов
Линии любви
Madrobots
Eplaza
Royal Forest
Илья Большаков
Москвич
контейнерные перевозки
FESCO
Nvidia
VILLA Outlet Center
база данных
ТРЦ Праздничный (Барнаул)
ТРЦ Макси (Тула)
PPL-media
Александр Харитонов
Росспиртпром
Herve Leger
fashion-ритейл
Геннадий Онищенко
Полина Бакшаева
назначение
ВкусON
Sibylla
HAKKI
Relish
Трансконтейнер
Familia Home
дикие животные
цветочный бизнес
Татьяна Сергеенко
Моя смена
Роман Шаталов
Дмитрий Филимонов
Маркет42
Ольга Тарноградская
спецодежда
Дмитрий Зубков
Владимир Балашов
Алексей Дементьев
Высшая Лига
Skywell
Ассоциация сотрудничества по развитию навыков и профессий
Центр-Инвест
МФТЦ Сказка
Рыбный союз
АДМ Moniron
онлайн-инкассация
Profindustry
Елена Захаренко
SearchBooster
Александр Головин
VDOHNI
Ассоциация виноградарей и виноделов
Hiper
нормирование
Александра Нямина
отсрочка от призыва
VM Partners
Дарья Мушта
копакинг
Сергей Каченов
брынза
E-tiketka
частичная мобилизация
ITentika
Greenwise
Артем Пономарев
Алексей Баров
Joomla
Drupal
Opencart
WordPress
G.R.E.E.N.k
Екатерина Трошина
Magic Group
универмаг SLAVA
Елена Попова
FITKIT
Никита Невейко
подменный фонд
подменный персонал
мицелий
2Mood
ТРЦ Галактика
ТК Амбар
ТРЦ Victoria Gardens
ТЦ Мини-Молл
ТРЦ Филион
CCC shoes and bags
ТРЦ Акварель
ЕвроОбувь
Монарх
Система Глобус
сдерживание цен
Esselunga
клубные карты
Столичная торговая компания
John Varvatos
Макси
Дмитрий Петровский
LidO
Ольга Чернухина
РСЯ
Дмитрий Апухтин
Ex-Bags
Goodvalley
Вестер
Кораблик
Delmar Family
Анфиса Еременко
RestCon
Елена Перепелица
Александра Кошкина
ДРТ
Dame
Maude
Everlane
Юлия Половинка
универмаг Телеграф
ТЦ Zеленопарк
Дмитрий Левицкий
А2:Research
Аптека.Media Ads
Eshopmedia
PharmaCosmetica.ru
Imprice
Никита Цуканов
Traton
Sber AI
Тони Майер
Тюменская область
Игорь Иванов
Российско-Турецкое торговое партнерство
РТТП
Александр Костров
Axenix
Jumbo Cola
Добрый кола
Powercell
ФудВэй
Николай Комаревцев
колл-бот
Дмитрий Грунин
Sony Music
Владимир Николашин
ГК Русское зерно
Punkt
Л-Пост
sexual wellness
ПУД
валюта
Мир Упаковки
Маревен Фуд Сэнтрал
Кирилл Лымарь
Segezha Group
Volga Group
АФГ Националь
консервирование
Sneaker BOX
Екатерина Сойак
Fosun Group
Диснейленд
Воронцовские сухарики
Дмитрий Комаров
Виталий Цыганков
Станислав Елисеев
live-шопинг
Eyebuy
Сергей Варт
Miss Universe
Мисс мира
ритейл-галерея
GTS
таможенное декларирование
Тинькофф Кассы
Wilstream
Оксана Панфилова
LF Logistics
Екристал
Machenike
Михаил Горбачев
Оксана Леонова
Major
кабачки
New Retail Forum 2022
Ozon Global
OmniCDEK
ShopClues.com
Bitrix
Logitech
заготовки
СДЭК.Маркет
телекоммуникационное оборудование
Кухонный двор
Александр Семёнов
HOUSE OF APPS
Виталий Литвиненко
Milford
iPhone 14
Parter.ru
краб
CUBBY
Анастасия Шишкина
Omni Pharma
Виндзор
Союзплодоимпорт
ОРТЕКА
RTM Group
Щелково Агрохим
Triumph
Dove
Полка X5
E-com Check-up
Lindab
Татьяна Симанихина
My Path Group LLC
Дмитрий Санников
Pochta Global
Турецкий холдинг FLO
Viciunu grupe
стоматолог
Русская косметика
Павел Сметанин
гастротуризм
iMac
Ozon Объявления
видеокарты
Amcor
пищевые отходы
Андрей Лесь
Miller
ночные клубы
Soho Rooms
Stars Coffee
Доброфлот
KIT SOLER
Userstory
Глобальное объединение по торговле услугами
Shoiberg
Константин Калинин
Ольга Широкова
Lada Niva Travel
чебуречная
FLO Retailing
Лидское пиво
Olvi
оператор рекламных данных
ТРК Пик
Wiko
Tchibo
Мария Багреева
Алексей Бакирей
Почтовая логистическая компания
Torgmoll
Крокид
Rеtail
SWIFT
SPS.Legal
Андрей Крупник
GEO.Platforma
Алексей Алексеев
Иван Смирнов
Валерий Меладзе
MVNO
iRobot
Groupe SMCP
Maje
Sandro
Лариса Зонова
СКР
Deutsche Post
Mir Pay
ресейл-платформы
Lexmark
Фармдистрибутор
Oltermanni
ТРЦ Торговый квартал
Сытный рынок
Okko
Fitmost
Капитон Смирнов
Тинькофф
Restomarket
гофрокартон
Project SMM Ingate
Александра Гурова
OmniLine
Александр Руднев
Еkaterra
FOTO-ONE
Максим Иванов
шеринг
Герман Раскин
Groove
italy & co
Альпина
NASA
Floo Family
постельное белье
Мясницкий ряд
Lamborghini
WEIS
ЛетуТех
Екатерина Рыжова
Анабар
Тимур Фахрутдинов
ФСИН
специи
Kamis
Валерий Трошин
ПроАптека
Фитнес формула
Анна Кожевина
Авито Доставка
стажеры
телеграм-канал
Дарья Протасова
Bulldozer Group
Positive Technologies
Литовские железные дороги
Алия Рубцова
GitHub
Citrix
American Express
Дмитрий Шестернин
Рестомания
Nhood
Fiba Holding
Мария Базюк
Jim Beam
Никита Черкасский
1 сентября
Владимир Ганяхин
Geranium
Restaurant Magazine
билборд
Lanvin Group
Норвегия
Александр Орлов
Николай Петровнин
Максим Черепанов
решение суда
BuyBrand
Ассоциация организаций продуктового сектора
АЙТОБ
Elopak
мультипикинг
Матвиенко
Hortex
стики
Александр Виноградов
догфудинг
Николай Хорт
Stopexpress
Вимм-Биль-Данн
Laimon Fresh
ГипермаркеР для СЕО
SteadyControl
Анастасия Коврижных
Дятьково
Алёна Шунулина
ЕС
Пицца H
Виталий Свидовский
Moulin Villa
Валентин Зыбалов
велокурьер
Карина Стельмах
Волжский пекарь
Булочно-кондитерский холдинг Коломенский
Анна Липина
TopMarketplace
R4S Group
АРТ Деливери
Legend of Moscow
Four Seasons
Zebra Home
фудтех
фотоотчет
Moneyplace
Анастасия Романова
CDEK.Shopping
Komipak
Сербия
Дарья Федорова
Максилак
Доппельгерц
Солгар
Herbalife
Сергей Чебанов
Radical Chic
Research & Development Ingate
Григорий Загребельный
Sales Up Now
Илья Ребров
Franchise Group
Аптека.ру
Zen Mobile
Елена Пикунова
комиссионные магазины
Bunge
Таджикистан
Фонд поддержки социальных проектов
процессинг
хайринг
CISLINK DTS
Spectrum Brands
Артур Тилябаев
Виталий Щупляк
Полина Воронина
Николай Ганин
Сергей Бузилов
Ярослав Тпругин
браконьеры
Ray Ban
Станислав Наумов
Анастасия Каверзина
Елена Самохина
Андрей Емелин
Эльман Мехтиев
Татнефть
Территория Фитнеса
Ирина Антоненко
Совет ЕЭК
Funky Monkey
Конфоп
лакокрасочные материалы
Tikkurila
шоу-бизнес
рэп
Marlboro
Центральный рынок на Маросейке
Александр Черников
платья
VPN
Марина Гладких
Рокет Ворк
Фаст Ривер
Екатерина Лобачева
Михаил Евстегнеев
Брянская область
Сделано в России
Л’Окситан рус
выход на рынок
Дмитрий Мазеин
Белгородская область
трейдинговый бизнес
Апрель
Sigma Messaging
Алексей Сергеев
Андрей Мякин
Белая пятница
Revlon
Юлия Волохова
Вкусно – и точка
Русклимат
Сибур
Марина Юркевич
некачественный товар
BNPL-сервис
e-pharm
Finlandia
Brown-Forman Corp.
Orient Group
Nikoliers
TheCultt
Retailme
Константин Жаров
Ernst & Young
DP Express
Курьер Сервис Экспресс
Кредит Европа Банк
Вероника Конкина
Андрей Никаноров
Александр Яковлев
Росгвардия
Андрей Аванесов
Михаил Харламов
НИЦ Безопасность
Олег Климочкин
Gerber
Александр Иванов
Ефим Кац
Система ПБО
Дарья Василевская
РСБУ
Нина Григорьева
Ассоциация банков России
Алексей Комаров
Станислав Воронин
iTAB
KPMG
ECOM Expo’22
Лантманнен Юнибэйк
Jacquemus
Авикон Технолоджис
Эдуард Бутаев
Дымшиц и Партнёры
Михаил Дымшиц
Креатегия
Ольга Подгорная
Гильдия Маркетологов
Игорь Березин
Первое Агентство по рекрутингу респондентов ADS
Илона Методиева
Est.1993
Stardogs
Wella
Ольга Штейнберг
Fashion прокачка
Кевин Ханда
Camper
KüchenLand Home
COM.E ON Forum 2022
Своё Родное
Дмитрий Тарасов
Невада
Dantone Home
Яндекс Плюс
Tech Week
Лев Киселев
Marketing Logic
Анастасия Бойцова
Hilding Anders
Станислав Богданов
iPort
ТРК Малина
Нефтьмагистраль
закваска
Tinkoff Pay
Prosus
Киномакс
IMAX
Владислав Кузьменко
Urban Tiger
Анастасия Пиорунская
Rusprofile
Ульяна Фадеева
Йокохама
Indesit
MSCI
Евгений Лукьянчиков
Mobile ID
авторизация
edna
Александр Дубровин
Олег Туманов
Сделано!
БлинБери
Светлана Копытовская
Александра Богословцева
Ассоциация европейского бизнеса
PR-директор
релокация
CUSTIS
VK Мессенджер
радиоэлектроника
Наталья Рычкова
Unique Fabric
BRUSNIKA
Pompa
Island Soul
Japan Post
RuStore
гофроупаковка
Stora Enso
сухофрукты
Tarkett
электронные документы
ЭДО
мода для беременных
Штефан Бургер
независимая гарантия
OTC.ru
Юлия Романова
Lactalis
SvetoCopy
Raisio
nePochta
шоурум
Александр Лозовский
TelecomDaily
Реестр организаторов распространения информации
Анной Саливон
Arrival
UniCredit
мука
М.Тех
Агава
Артур Гирфанов
лид-магнит
Роман Роменский
ЦентрКредит
CHERY
TeamViewer
кожевенное производство
ЯRus
Tenchat
SKIMS
Гурманика
Транс-Миссия
Грузовичкоф
Оксана Козыренко
La Datcha
СЛОН-ЭЛЕКТРОНИКС
Белёвская
Глеб Семерня
Ahmad Tea
Матвей Гулин
Арсений Ушаков
Екатерина Быкова
ROMER
Виталий Гайдарович
Colin's
Талип Жуманазаров
Виолетта Минина
электроинструменты
Haribo
Боржоми
РУМ
MAYORGO
My Organizer
Семишагофф
Зaмания
Финестра Оптима
Ferroni
Бауыржан Рустемов
JT Group
Кемеровская область
Анатолий Сморгонский
ensi.tech
IBS
Сергей Мацоцкий
Анкетолог
Марина Мамонова
Денис Марфутин
Elko grupa
Li-Ning
ГК ФСК
фудмолл VOKZAL 1853
RedExpress
Станислав Краснояружский
Алексей Бездеткин
CORE.XP
Gorserv
Андрей Яценко
Вера Ларютина
GDR
Такси Максим
Ассоциация производителей альтернативных продуктов питания
машиночитаемая доверенность
TerraLink
Сафиуллина Зарина
Davidoff
Евгения Арнаутова
Анна Иоспа
Надежда Бабина
CLOUDSET
КБК Черемушки
Continental
Матемаркетинг
Coffee Analytics
Подари планете жизнь
Наталья Еремеева
Яна Абалымова
Skype
Ольга Яшина
SlickJump
Imredi
McKinsey
QuickCheck
Holy Corn
Алиса Басырова
RuMarket
кулич
Поставка.рф
электронные чеки
фуры
People&People
Людмила Коваленко
Контур.Маркировка
McDelivery Detector
Coffee in
UPGRADE RETAIL Лето 2022
Huhtamaki
Минэнерго РФ
Hartens
TJ COLLECTION
Moulinex
Rowenta
Филипп Вольнов
Яндекс Лапки
товарный знак
EXMAIL
Лемниската
Любовь Савина
визы
3D-ГЕНЕРАТОР
Изварино Фарма
ПРОМИС
Хельсинки
EPAM
Мария Ерунова
Фрифлекс
имбирь
MarTech
контактные линзы
Простоцветы
антикризисный маркетинг
Самарская область
Vici
смерть
Trend Island
Иван Труфанов
Rutube
Kingspan
Арнест
сервис бронирования
самоклеящаяся лента
чековая лента
Денис Добряков
Miss X
I am pijama
Анастасия Якушева
Zeri
Валентина Мамаева
Наталья Петрова
humex
Евгения Палевская
ТРК Армада
ИНПРОМ ЭСТЕЙТ
Smart TV
Светлана Люлюшина
Яндекс.Видеосети
Озон Банк
Инна Походня
X5 Digital
Ненецкий автономный округ
Грядка
RusTobacco
Goodt
Нелли Мамян
HiPP
Колорлон
Demis Group
Виолетта Лукашова
семплинг
GOLDSTICK
Дмитрий Шалугин
Hesburger
Продимекс
Павел Тулубьев
Lagooon
АНО Цифровые платформы
NashStore
Инсайдер
DDX Fitness
Владимир Курдин
Понимаю
Татьяна Шкуратова
Tetra Pak
Ситидрайв
НАФИ
спикеры
видеораспознавание
Sendsay
Глеб Кащеев
ТК ЕКА
видеореклама
Western Union
онлайн-касса
Кирилл Хаустов
Pinskiy & Co
Пинский
нацпроекты
производительность труда
Петр Марков
Корпорация МСП
Golden Duck
Ozon fresh
DashaMail
Юлия Рожкова
Chitir Chicken
Максим Шаскольский
Наталия Матвеева
Еком банк
Алена Ахмадуллина
I Am Studio
Олег Воронин
Татьяна Валентович
Наталья Войнич
Елена Кадыкова
Daniela Uribe
Pink
George at Asda
Eli Lilly
Россграм
Автологистика
Надежда Петрова
Imperial Brands
ZV DIGITAL
Степан Зайцев
оплата по QR-коду
Делобанк
Ирина Кузьмина
российские вина
Крошка-картошка
Феликс Евтушенков
YULIA KUTUZOVA
Юлия Кутузова
Лилия Войцицкая
Павел Бедненко
Михаил Полубояринов
Jack Daniel's
Play Маркет
XWAY_MMP
селлер
Джемма Голдфингл
Петр Краснов
Oozor.ru
Анастасия Курганова
Level.Travel
Gerry Weber
Ирина Хоменко
Сибирикс
LUSIO
Мировые цены
First Data
Александр Старостин
Fazer Group
CUVEE
Sunone
Turbantik
Eggheads Solutions
Катя Солнечная
Diablo marketing
Наталья Карпова
Ольга Пелевина
Estel
Paramaount
Electra Bicycle Company
Luding Group
iWengo
Nemiroff
Тимофей Шиколенков
УК IPFM
Павел Люлин
военная операция в Донбассе
Александр Котов
Tamaris Comfort
Анна Мигаль
Lazada
BelkaCar
Retail TECH 2022
Gulfood -2022
война
Нурофен
воспринимаемая ценность
LIFE PAY
Арсений Косенко
Первый Мебельный
lazurit
Продэкспо-2022
Good’s House
Алексей Юдин
ПЭК: MALL
Кирилл Савченко
профсоюзы
Бета ПРО
хэдмейд
Livemaster
Юлия Старко
Sapiens Consulting
Роза Хутор
Елизавета II
Старик Хоттабыч
Виктор Грязнов
Илья Макаров
Рената Литвинова
Centric Software
эмигранты
очистители воздуха
Dmonstudio
Картофельный Союз
Банк Восточный
Виталий Шахматов
ТРК Глобал Сити
Архыз
Radar
Татьяна Шашлова
Victoria’s Secret
Вкуснотеево
ГК Молвест
DHL
ГК Автомакон
DataLab
SAP TM
Grotem/Drive
Муравьиная логистика
ЯКурьер
Maxoptra
Мегалогист
Кирилл Иванцов
EgoMall
Дизайн Склад
Ассоциация предприятий мебельной и деревообрабатывающей промышленности
Артем Кузьмичев
Студенческие Игры 2023
минимальная розничная цена
Аллея
ЗОЖ
Ариант
TalentTech
Артур Налбандян
сидр
NC Logistic
Артем Пичугов
Баста
QVALON
Ирина Ткачук
Datmark
Бушуева Мария
pharma
Фарма
Виктория Кузнецова
Владислав Свириденко
Peloton
Липецкая область
StockX
Калужская область
Ассоциация Теплицы России
Jacobs
ESG
CX
CJM
Customer Experience
Цифровая платформа МСП
День всех влюбленных
14 февраля
brobrolab
Retail Prophet
Даг Стивенс
Август Мейер
Hornbach
Террасофт
Shutterfly
WooCommerce
Shopify
on-demand
Print Bar
Александр Володарский
Craob
Restik
Paolo Conte
Halls
Мон’дэлис Русь
Mondelez International
Дирк Ван де Пут
Елена Шейнкман
Наталья Леонова
Евгений Капустин
Out-of-Stock
ТРЦ Ultra
агрегатор такси
publicrelations
Александр Якимец
Сергей Крючков
Национальный союз производителей пива
Мероприятия
GoMarket
ТЦ iMALL Эспланада
Зенон Ивашкевич
ССС Group
Гатчинский спиртовой завод
ТЦ Солнечный
межбанковская комиссия
Линзмастер
онлайн реклама
фрод
MediaNation
Никита Шамин
Steve Madden
Dunelm
DECIEM
налог на прибыль
ОАЭ
ПоПолочкам
РПЦ
Федеральный экологический оператор
Всесмарт
Долями
Trend Micro
Михаил Кондрашин
монеты
Монетная компания
Firdaws
Минэкономика
Ozon Profit
Wildspace Shop
Валерий Миронов
Дом Chkalov
Svalka.me
Национальная палата моды
Сушков и Дель Песто
SE Ranking
SEO-платформа
NRF 2022
Publicis Sapient
Хилдинг Андерсон
Yolka
Maserati
Авилон АГ
TEAM 7
Profil Doors
трекеры
Доширак
продукты быстрого приготовления
Ролтон
Тинькофф Кредит Брокер
Think with Google
ITSM 365.Outsource
Юрий Новокрещенов
Леонид Агутин
Борис Попов
Kohl's
Национальный каталог
Buyback
Gaia
химчистка
модельер
Мюглер
С-Консалтинг
Слышать Вместе
Евгений Сафронов
Яна Бубнова
Verdict
ExpressVPN
Take’N’Go
Илья Трошин
WB Card
Розница-мать
Тамбовская индейка
консолидация
коучинг
коуч
SuperJob
Tempoline
Roblox
Quick's
RetailDetail
Полин Нирман
Йорг Сноук
Красный дракон
Галс-Девелопмент
eLama
Дарина Калистратова
Hikvision
LOYMAX
органика
Русская рыбопромышленная компания
Алексей Кулаков
Владислав Курбатов
Анжела Рябова
Дешево
Обнажённые сердца
Алексей Карев
Pre-IPO
GSK
Хабиб Нурмагомедов
Jameson
Loginet
Элиза Кремнева
NFT
КАЛЯЕВ
ГК КиН
ГК Алвиса
Сердце России
Планета Здоровья
Total experience
Евангелия Смирниотаки
TON
diHouse
GoodsForecast
автозаказ
Денис Чигаев
Nebbia
EA7
Polo Ralph Lauren
Jacadi
Dirk Bikkembergs
Marc & Andre
PitBull West Coast
Luhta
Smekalka
Приморский кондитер
SaaS
Таксиагрегатор
CWF
АРИО
ОСГ Рекордз Менеджмент
Максим Семенихин
поколение Альфа
Leclerc
Галерея Чижова
social commerce
Авито.Товары
Иван Гуз
Туркменистан
Maybach
Sistema SmartTech
Группа Продо
птицефабрика
беспорядки
Orange Business Services
Робин Де Кейзер
Валерий Ковалев
Фёдор Овчинников
Chipita
Gallina Blanca
Алексей Мерзляков
Николай Орлов
Эдуард Ахрамович
Михаил Гончаров
Татьяна Володина
Михаил Славинский
Елена Никитина
Вера Бояркова
Рясова Ксения
Вера Брежнева
дактилоскопия
аптека
программисты
Омикрон
social eCommerce
Дмитрий Рябинин
Яков Пейсахзон
Тинькофф Shop
кошки
ТРЦ Союз
ТЦ МегаГРИНН
Заодно
Киргизия
АПК Михайловский
WGSN
Александр Кулибаба
Монастырев.рф
Сергей Егорушкин
HealthStore
Азамат Ибатуллин
Евгений Шкут
Станислав Горшенин
Арина Аванесова
Антон Букашкин
Андрей Шаповалов
SberX
Евгений Щепелин
Владислав Широбоков
Epicstars
Анастасия Ермошина
Levi Strauss
Cdiscount
CapCut
Zenly
Pioneer Group
Авто-Авангард
КАЗАНЬЭКСПРЕСС
Little Caesars
KION
MEGOGO
Respect
Артсана Рус
Chicco
Дмитрий Кудренко
Composable Applications
Дмитрий Зимин
Грузавтотранс
Пулково
клиентоцентричность
Владимир Корчагов
Александра Москаленко
quiz-маркетинг
Алексей Гордеев
Общероссийский народный фронт
валенки
Rivoli Perfumery
Signature Faces
Melvita
Natura Cosmeticos
Decléor
Carita
Raylon Corporation
L'Oréal
X5 Import
РОЛЬФ
Михаил Ефимов
Yeezy
KKW
Партия Еды
online-only
Cuore
Николай Новоселов
Яндекс.Реклама
Игорь Рыбаков
Simple Group
Heidrick & Struggles
RosExpert
Матрица
Юрий Вронский
Samsung Pay
Свобода
Ganni
Submission Beauty
G-Star
ThredUp
Madewell
Rens Original
Set Retail 10
Set Mark
Посуда центр
Бульварное кольцо
голубика
Группа Самолет
самолеты
OBOZ
Mohito
Cropp
Major Terminal
Major Cargo Service
Татьяна Одушкина
Анна Былинкина
Алексей Хуторной
Антон Пыльнов
Александр Самотаев
Юрий Павлюк
Максим Загоруйко
Martini
Bacardi
Индекс глобальной интеграции DHL
Игорь Дериглазов
Emirates
Craigslist
СBRE
Юлия Назарова
Антон Алябьев
Ирина Ушакова
Сатурн
Мегастрой
Планограмма
ТехноМерч
Евгения Бусина
Distributed Enterprise
Dogecoin
СТС Love
Кирилл Степнов
ТЦ Филевский
ТЦ Столица
RTFKT
Нарзан
дистанционное обучение
Виктория Кучеряева
Ключавто
Владимир Кириенко
удобрения
Андрей Соколенко
Светлана Сарычева
Эльдар Курманов
Тигрус
Хенрик Винтер
скандинавский стиль
Ольга Калоева
банковские продукты и услуги
Tablogix
Michael Kors
Missoni
Christian Dior
Data Fabric
Артемсоль
VTB Pay
Магнит Go
Екатерина Курылева
Роман Есаулов
R4S
Яндекс.Про
Кубань-Вино
ОКВЭД
Индекс аптечки
Sees Group
Денис Кутергин
Miele
Сантехника-онлайн
Socolor
Pharmacosmetica
Shophair
Сплав
Ароматный мир
World Class
Антон Чесноков
налоговая проверка
Юлия Павлова
Норман-Виват
InJapan
Etsy
Газпром-Медиа
Ozon Dom
merchcomm
vertcomm
Антон Верт
даркнет
Вкусмилл
Анастасия Василькова
Арентер.ру
Сергей Степанов
O1 Properties
ADV
SKYMEC
Антон Ларсен
Дмитрий Востриков
Salzburg Schokolade
Владимир Погонин
ECCCSA
Место встречи Янтарь
Edison Technologies
новогодние елки
Станислав Ясаков
СеллерМАРКЕТ
Анна Шафигуллина
MELENIM
Алёна Белова
Анна Держаева
Rerooms
Альберт Худоян
контрольная закупка
Адвокат Премиум
Леонид Ковалев
Levadnaja Details
Ushatava
Monochrome
Роман Уралович
VR-очки
букет
соевое мясо
ТРЦ Oceanis Mall
Эдельвейс
Деньги Вперед
Sqwin
Оксана Степанищева
Контур.Маркет
Владимир Поздняков
Детмир мини
Qmarketing Academy
Pampers
Малышарики
Смешарики
Рики
Марк Завадский
Михаил Уржумцев
финансовая отчетность
Павел Девяцкий
Q1 Group
Стивен Ньюман
Евгений Ноткин
поддержка бизнеса
Friso
M.Club
Дмитрий Репин
Михаил Иванцов
Татьяна Янышева
Михаил Губергриц
Гармония здоровья
Паркет point
Металлинвест
Булочные Ф.Вольчека
PeopleWare
PIPA Chemicals
BORK
дефицит кадров
Giant Food
ультрафреш
Все Прилавки
Эдуард Болмосов
Profi.ru
ГК Основа
Jinga
VAIO
Тайга Систем
Runcible
Сергей Анищенко
Qugo
CVC Capital
Алексей Корягин
Рыбинск
X5 Карта
Анастасия Кравченко
Fabrique.ai
Сергей Кедров
Boomerangme
Grubhub
Дмитрий Москаленко
Олег Войцеховский
Виктория Смирнова
Евгений Скориков
алкопродмаркет
ПокупАлко
Покупочка
Сергей Савонькин
Дарья Жигалина
Эмануэле Джомми
микробизнес
Горздрав
Валентина Бучнева
Александр Фонарев
Никита Блинов
Андрей Молчанский
IRNBY
DNVB
Digital Native Vertical Brands
store as media
SOHO Fashion
Scholl
Есентуки
LETOUT АУТЛЕТ МОЛЛ
экзоскелет
OneRetail
Гиперглобус
Sea of spa
Olivetti
Orion
Pioneer
Илья Островский
Дмитрий Сергеев
техпартнеры
Шольчев
Евгений Шольчев
Николай Тимофеев
Thomas Sabo
Rakuten
Tealium
Линдси МакЭван
Александр Бичин
Игорь Плетнёв
Анастасия Тимофеева
Алексей Танаев
Segway-Ninebot
двасэнсэя
магазин для взрослых
сексшоп
Вера Зименкова
Яндекс.Бизнес
Юничел
обувная промышленность
Минпросвещения
Олант
Мария Осадченко
Станислав Мальцев
Алексей Чупин
Нитика Шмелёв
Мария Бурмистрова
Ольга Тесля
Михаил Зайцев
Черноголовка
Garmin
Михаил Хохлов
Масложировой союз России
Илья Красильщик
Антон Денисов
Метавселенная
Martlet
Центр речевых технологий
речевая аналитика
POS-кредитование
Дарья Золотухина
Хамзат Хасбулатов
Ассоциации предприятий кондитерской промышленности
Николаем Матвиенко
Danshen Liang
Joyoung
Dalongyi
Xiaolongkan
Haidilao
Girl in mall
Софья Щукина
data-шеринг
гиперперсонализация
Кристина Обухова
Наталья Толкачева
Наталья Притыковская
Рашид Исмаилов
Илья Кашин
Рольф Ладау
Ольга Гавриленко
Штеффен Хоффманн
Мауро Сабатини
Алексей Воробьев
Максим Кузнецов
Вячеслав Николаев
Борис Маца
Мария Гутьеррес
Степан Мастрюков
Станислав Крупник
Андрей Лукашевич
Михаил Махьянов
Константин Смородинов
Ольга Флоренцева
Юрий Мисник
Татьяна Кожевникова
Георгиос Полименакос
Itella
Юрий Соклич
Алина Кисина
Benetton Group
БЕЛТЕЛ
Дмитрий Савельев
Ульяна Власенко
Валерия Солок
Welldone
Юрий Долженко
Новосибирская область
Екатерина Борискина
Евгения Шиповникова
эмодзи
Марина Харитонова
Mercadona
Ярослав Шиллер
Марина Змеина
LaRedoute
Игорь Гусев
Syoss
сэмплинг
Rexona
Nivea
Palmolive
Colgate
маркетолог
Екатерина Савоськина
Hertz
Совет профессионалов по цепям поставок
Деловая среда
вафли
Первый Бит
Ольга Артюшкина
Таксовичкоф
CDP
Анастасия Кутасова
Новгородская область
Mealjoy
Solid
Юрий Кандела
Fortnite
Wallmart
Lingualeo
Lotte Mart
Samyang Ramen
Green Grey
Lia
Ozon Rocket
Meta
Neste
Газпром-нефть
Наталья Усманова
микрозаймы
Владимирская область
Татьяна Юркевич
микрообучение
Антон Темников
Екатерина Сотник
Halloween
Помощь рядом
Дмитрий Иванов
Людмила Подъяпольская
ТРЦ HOLLYWOOD
голосовой бот
Dasha AI
Александр Зайцев
Наталья Чиненова
Владислав Светлов
LaimaLux Group
Игра в кальмара
ТЦ Гранд Сити
Полимерстрой
Konigsbacker
ТИМИГОР
DIVAN BOSS
GrowMe
Velvet Season
Mustang
Inglot
мерчандайзер
Вадим Солынин
Дмитрий Макеев
Страна Девелопмент
ТРЦ Среда
UTEAM
Союз участников рынка картофеля и овощей
Sphere
Антон Антропов
Libra
Frencia
nu-in
NAGNATA
Cou Cou Intimates
UNLESS
экоодежда
Professional FM
Александр Устинов
Mr.Ricco
Национальный Союз Хлебопечения
Мобильный ID
Сергей Малютенков
Lyle & Scott
AppAnnie
нерабочие дни
FSC
There Was One
маршрутизация
ЛИСАД
BIA-Technologies
Александр Тихонов
Clicker
Арсений Шистеров
TikTok For Business
Росприроднадзор
нетмонет
торговое промо
shopper marketing
ПЦР-тест
Мужское государство
Российский союз виноградарей и виноделов
Леонид Попович
trade-marketing
рекламные агентства
А1 TEAM
Диана Долгушева
Carbon Production
Черёмушкинский рынок
Экспресс-скан
Птичий грипп
VK Видео
Face Pay
Союзконсервмолоко
PNK Парк Домодедово 1
Магнит Аптека
Ютека
X5 Transport
X5 Банк
X5ID
X5 FoodTech
Digit Trading
Данил Концевой
TAdviser
games.ru
Игры в кальмара
Владимир Слинько
мясо Bite
Le Journal Intime
PHARMA-ECOBOX
MYBOX
Вячеслав Филимонов
АтлантКонсалт
Сергей Прокопов
Ytips
Яндекс.Чаевые
Продскладъ
Авоська
Сергей Солонинк
Human Cloud
Антон Никеров
гайдлайн
наггетсы
Ксения Борцова
Лапушка
Наталья Горская
Белкоопсоюз
Елена Мельникова
Елена Мельниковаё
Сергей Глушков
сервисный сбор
MoPub
РОЦИТ
Ярославская область
Unagrande Company
МЦД
SKLV
Клава Кока
кассы-трансформеры
Waitrose & Partners
Sainsbury's
CHARGED
брошенные корзины
Иван Ярославцев
Татьяна Умряева
Ирина Меньшикова
банковские гарантии
МТС Cloud
Set Retail
FERO
smart fashion
Яна Беккер
Дорогомиловский рынок
Надежда Ланчикова
умные колонки
digipharma
День учителя
Bounty
ПТИР
Mark Formelle
ShopChat
SimbirSoft
Анна Шведова
Светлана Кузнецова
поделки
ручная работа
Андрей Завадских
United Investors
The Kooples
медиапроекты
сервис Пульс
eGrocery
интерфейс
Наташа
Брест
Novo BI
Павел Синицын
ТРК Броско Молл
ТРК Новомосковский
Даня Милохин
IQOS
My Food
ТРЦ Рамус Молл
Нижнекамск
теплицы
TOMSOYER
Артур Рощенко
Изабель Марант
Pre-Spring
Y2K
Missy Empire
Motel
бумеры
Союз российских пивоваров
Регина Тодоренко
Виктория Алеманова
умные очки
тушеная свинина
PLT Чехов
Аскар Рахимбердиев
Яршинторг
Реал Инвест
TOPTOP
СтройПроект
BNPL
S7 Airlines
Объединение административно-технических инспекций
ТЦ Гагаринский
Hoegaarden 0.0
eCompass
Food Temple Group
Союз производителей продукции на растительной основе
Союз независимых сетей России
НБКИ
Владимир Урбанский
Алексей Скоробогатов
РФРИТ
convenience store
Comme Des Machines
Ministry of Supply
аддитивные технологии
Максим Канищев
фудшеринг
Velle
Акушерство.ру
FineDesign
FineDesignGroup
Иван Бесчастнов
Севергрупп
Uber Eats
Сладкая жизнь
PRTV.su
Yappy
Магнит Экстра
Hansa
Docrobot
СберКорус
Ксения Хизова
цифровые продукты
продакт-менеджер
Микаэл Гелецян
Next2U
Григорий Лепс
СК Армада Парк
Умная энергия
Shell Café
Анастасия Жбанова
коммунальные услуги
защита прав потребителей
поиск сотрудников
ВЕТНА
новый налоговый режим
Costco
Контур.ОФД
Оксана Кобзева
Tevian
Ivideon
Cillit Bang
Harpic
Vanish
Finish
Lysol
Reckitt
Самуэль Пайола
Jiffy
Максим Гришаков
Юлия Грачева
МФК Саларьево
ТРЦ Облака
WorldFood Moscow
Елена Пудичева
Руслан Умманов
Bestseller Group
Директ Кредит
Дом Зингера
убийство
SRM
Светлана Ермакова
Mom.Life
X5 Ready Food
Ассоциация малоформатной торговли
Tap on Phone
интерчейндж
Светлана Кузьмина
Oskelly
Наталья Пилявская
Евгений Мищенко
Google Sheets
Наталья Вишанкова
The Whisky Exchange
Retail Business Russia 2021
Search Booster
Черкизовский рынок
Masterpass
Вера Иванова
Александр Козлов
Екатерина Варнава
Ирина Кандиболоцкая
Head & Shoulders
буллинг
Радеж
Яндекс.Взгляд
беспроводные зарядки
ТК Рублевский
ТРЦ Galileo
ТРЦ Аквилон
Денис Евстигнеев
антифрод
ECOMMPAY
Даниэль Шевский
Купи Продай
Александр Муратов
Эльвира Набиуллина
рефил-станция
MyHermes
U.S.PRO
Тимофей Счастливцев
больничный
утепление
Arçelik
Grundig
велопарковка
DTC
снятие с продажи
Илья Елпанов
Данил Шелехов
сторителлинг
флекситарианство
финансовая грамотность
HelloFresh
Сергей Паньков
Союз потребителей Российской Федерации
Елена Воронцова
МФК Кунцево Плаза
Руки.ру
Максим Трухин
Мэри Гукасян
ДаемДеньги
гид Мишлен
дезинсекция
банковские отделения
Эдуард Шанев
Владимир Савкин
Михаил Платонов
Мария Золоткова
Владимир Комлев
Леонид Зондберг
ГлавДоставка
YouTube Vanced
Вертолеты России
GetContact
OK.RU
Анастасия Пятова
Ольга Зиновьева
Reshape Virtual Summit
Олег Пароев
Алексей Семенов
UberEATS
коливинг
Solar MSS
Тимур Ибрагимов
отравление
Бравлы
Blue Sleep
процессоры
картофель
Карина Погосова
Владимир Холязников
алмазы
закрытие ресторана
Татьяна Гура
Александр Ведяхин
авиасообщение
Кабардино-Балкария
Ирина Коршунова
СберСтрахование
Экологический союз
Федор Павловский
Марья Дэй
ТЦ Европарк
Денис Косенков
РАЭРР
Мария Чернышова
Мария Живых
Антонина Цицулина
Лолита Милявская
Анна Щурова
Qrator Labs
Organic Shop
Наталья Смирнова
реселлер
The RealReal
LolaVie
STANFOOD
Texel
бот
Инглекс
Тетрика
Skypro
Юлия Вершинская
мониторинг цен
Александра Шестакова
Евгений Антипов
Мобиус
Глаз бога
Даниил Фёдоров
IT-компании
Артем Вяткин
Data Scince
LOLOCLO
Юлия Терентьева
Brooks Brothers
Алексей Иванов
SberCloud
Отари Меликишвили
Центр развития цифровых платформ
Настя Ивлеева
отмывание денег
NielsenIQ
маркетинг
Payture
ОТМ
QIWI Box
Дмитрий Заикин
fintech
ETALON GROUP PLC
Марат Артуганов
Анастасия Ракова
Анатолий Попов
Ассоциация Цифровой транспорт и логистика
De'Longhi
Navigator Acquisition Corp.
Михаил Зверев
МЕГА Терраса
Carboma
POLAIRGROUP
Полюс
Вадим Батухтин
Gartner
Энди Джесси
Михаил Александровский
Borzo
Jifiti
Global Rus Trade
Weibo
Анатолий Мохов
УК Форвард
Юлия Гонтарь
Анатолий Орлов
VK Почта
АлиИндекс
Олег Резников
Баку
Евгений Давыдович
Максим Онищенко
никотиновые пэки
Гулливер
Александр Филаретов
Илья Тимченко
Ольга Ворошилова
Алексей Курдюков
Купчино
кавист
Мегамарт
Ольга Свечникова
Михаил Глухов
Антон Забанных
Сплит
Сергей Шнуров
Анатолий Кайро
движение
Марина Ильина
Павел Вяткин
Влад Широбоков
Анна Племяшова
TSMC
Temellini
CoStar Group
Великий Новгород
CP Foods
adidas Originals
Booking.com
New Guards Group
Прикамье
Виктор Грюн
Eden Springs
UVENCO
ТЕРРУАР
Ёбидоёби
Константин Зимен
Анна Петрушина
фермерский кооператив Калина-Малина
микромаркет
Manila Grace
европейские бренды
Smart Casual group
Надежда Амрани
Kaufman
IXR
Михаил Глеба
Евгений Волошин
банковские счета
Walmart GoLocal
Spark
политический кризис
талибы
Groupe SEB
ТРЦ Балтия Молл
EBITDA
ActiveCloud
Катерина Радюк
Бернацкая Юлия
Redmi
Mi
Ингрид Бродин
Центр электронной торговли
Сергей Лебедев
Маркетплейс.Легко
Виктория Абрамченко
сапборд
Алексей Ширяев
Анна Мазурик
МЭЦ
Алексей Кучвальский
ТЦ Арена Плаза
Verzuolo
B2b-маркетплейс
возврат средств
Noun
Dorogobogato
аутстаффинг
SkillStaff
Маруся
Сергей Крупнов
Ольга Самойлова
Priceva
Sweet Market
Байрам
роботизированная техника
Огонёк
Сокольники
Царицыно
Кузьминский лесопарк
Измайловский парк
Елена Меньшенина
Old Navy
EdTech
Авто-ПЭК
Scan&Go
комьюнити
Vione
Николай Музыка
наследство
CloudMTS
КуулКлевер
искусственное молоко
Faretti
Глеб Козлов
Маркет.Операции
Афганистан
Евгений Черешнев
Румыния
анализ продаж
PlayToday
MPSTATS
Дмитрий Черобаев
Арбат. Управление инвестициями
Александр Ушаков
репаты
Алтайский бройлер
нитраты
Анапа
DS Daily
TVОЯ Pizza delivery
Main Mine
Олег Джулаев
Национальный союз защиты прав потребителей
Георгий Акопян
Артем Кумпель
Тимур Валишев
Библио Глобус
Шереметьево
мобильные игры
Edited
Михайловский девелопмент групп
Tax Compliance
коллекторы
Radario
Кассир.ру
Ксения Лысенко
Livat
digital skills
потребительский спрос
support retail
Никита Тихвинский
Rush Agency
Руслан Кудрявцев
Шеф Перекрёсток
Александр Блинов
Fastuna
Кирилл Шерстобитов
Tony's Chocolonely
брендинг
LINII
Дмитрий Буренко
стадионы
ТЦ Никольская Плаза
Kantar
Игорь Данилов
CloudTips
Герман Галанов
Аскар Ахметов
Окраина
Вайлдберриз банк
Марк Карена
Антон Котяков
группа Ленинград
Сколково
Kids&berries
Stories
Сергей Воробьев
Цифровые технологии ритейла
Михаил Ланцов
СОЮЗНАПИТКИ
Neva Towers
Metrika Investments
Андрей Зюзин
социологический опрос
Елена Богатырёва
подержанные товары
Кира Матвеева
EAZZYPIZZY
фестиваль еды «ВКУСНО!»
ряженка
OMNI Solutions
Ефим Алдухов
Галамарт
Дмитрий Пивоваров
новые функции
Pay-платежи
электронная торговая площадка
Vertical Food
Chibbis
Роман Копнин
Илья Лавренов
Бангладеш
SANKUANZ
Галина Белоусова
Halewood
ТЦ «Леденцовопарк»
ТД «Петропавловский»
бизнес-литература
ГК ЭФКО
Foot Locker
SimpleEstate
Никита Корниенко
социальный контракт
Ольга Баталина
Биоферма Кубани
Национальный союз производителей и потребителей органической продукции
Андрей Спивак
Анна Гарманова
Скрепка
EGOISTE CAFÉ
EGOISTE
Катерина Инна Александровна
Webit
Сергей Емельянов
помада
прайс-чекер
Анна Орлова
Кирилл Пуртов
Кирилл Доронин
Finiko
SCARLETT
собственная кулинария
OSMI Cards
Александр Гаряев
Доктор рядом
Илья Салтанов
ТрекМарк
Алексей Ионов
Александр Винокуров
Александр Шохин
«Красная цена»
ТЦ «Агора»
IMSHOP.IO
Ксения Дроздова
Максим Карпин
адресная помощь
Артур Александрович
Мегаполисресурс
ЦВ Протек
PNK Парк Пушкино
Даниэлла Катари
Woolrich
Влад Вольфсон
Дмитрий Глухов
Анна Хилькевич
GVA Sawyer
канцероген
«Восточный Союз»
Татьяна Борзых
Русич-Холгомогоры
Face ID
Touch ID
Андрей Загребелько
перезапуск бренда
Feelunique
Dr. Oetker
Партнер-Электро
Александр Лысак
Ассоциация Индустрии Товаров для Здоровья
кнопочный телефон
АО «Байер»
Тамаки
Андрей Белянин
Savage x Fenty
Parade
J.Crew
Yango Deli
USHATÁVA
MIXIT
защитная маска
YouDo Бизнес
WORTMANN
Авиасейлс
Meet Visa
Factorin
ОРИЕНТИР
Ольга Кашкарова
Алиса Юрченко
Industrial City
Сергей Ахметшин
Аэромакс
CLARINS
онлайн-гипермаркет
сабо
Fetch Robotics
наложенный платеж
ЮSelf
Новые Ватутинки
Парижская коммуна
Александр Никитин
жёсткие дискаунтеры
Чижик
Олег Баландин
CPA-сети
нативная реклама
HalloApp
Расширенная ответственность производителей
Off-White
Андрей Павлович
День экологического долга
Madeleine
салаты
отгул
Broniboy
Александр Радионов
UNITY
Татьяна Кабешова
Glorax
Игорь Караваев
IT_2
ПДД
Сергей Миронов
канцелярские товары
вентиляторы
ГК «Орими»
TESS
себестоимость
Mercury Retail Group
MGNTech
Иван Круглов
ТРК Балканский
тетрис
ТРЦ Ташкент Сити
Vogue
Ералаш
Запорожец
Tiburon Research
реферальная программа
Вячеслав Володин
Иван Хохлов
Ассоциация Индустриальные инновации
одноразовые батарейки
отстранение от работы
Vnukovo Premium Outlet
Terminal Foodhall. Vnukovo
Анна Шумилкина
Gree
Midea
Zanussi
NeoClima
Lessar
Валерия Вебер
Shein
МЕГА Нижний Новгород
татуировки
Everink Tattoo
Virgin Galactic
Vectura Group
Philip Morris International
ELIS
PwC
JOYKIS
НМЖК
Анна Лебсак-Клейманс
Московский инновационный кластер
Authentic Brands Group
X5 Idea Challenge
Вероника Никишина
Kenkoh
Ольга Чернега
Евгений Римский
видеоаналитика очередей
ТЦ Discovery
ООО «Кондитерская фабрика «Мишкино»
Агрохолдинг «Ситно»
Moose Knuckles
Центр управления городским имуществом
Eroglu Holding
Loft Jeans
Лилия Дерябина
Йорн Арнхольд
Игорь Овсиенко
УЕФА
Евгений Джамалов
Accent Capital
ТЦ Сокольники
Aura of Bohemia
Кулинарная лавка братьев Караваевых
Техскладлогистик
Raven Russia
Ghelamco
SoftPOS
Елизавета Романова
Teatone
Комсомольская правда
кросс-промо
Лейдна Криштовао
Vitamin
LPgenerator
кикшеринг
электросамокаты
Whoosh
Urent
Марина Голомаздина
PayDay
Банки.ру
Максим Марченко
Прелесть Professional
СИТНО
Василий Большаков
Алексей Скатин
Казпочта
League of Legends
New Retail Forum 2021
BELUGA GROUP
food.ru
Николай Шестаков
карта Копилка
Хороший
Босналек
Наталья Соловьева
Мегаплан
Виктор Линник
Андрей Астапов
Пирна
Александр Бутин
Технопоинт
XWAY
Антон Ларин
MOSSMM
HR-UP
Cornerstone
Мясо&Рыба
Lime
ЦКТ
Денис Вишняков
Вадим Ибрагимов
Glincom
Мария Стогова
Владимир Садовин
Золотая Балка
Leomax Group
Ян Примус
РЭУ им. Плеханова
Виталий Дырдасов
Респиратор Бабушкина
Тимур Ланский
Анна Клинскова
Кирилл Набиев
Алина Рыженкова
Полина Гагарина
VisionLabs
mos.ru
Александра Шакола
Get Faster
SeasonMarket
Juicy Food
Михаил Воронин
Disco Corp
воркауты
Галина Ящук
Яндекс.Объявления
Calliope
бигтех
Дмитрий Скиба
Admitad Affiliate
Тинькофф Касса
зеленый чай
Евгения Ламина
Виктор Христенко
СберЗвук
Арам Сапонджян
Алексей Козловский
Андрей Амосов
Елена Шульгина
Дарья Гузева
Зоя Кайгородова
Wickr
Buyk
Оксана Трофимова
Павел Глухов
Екатерина Сомова
транспортный ритейл
Московский транспорт
Владимир Кондратьев
FoodBand
Дмитрий Спиридонов
Российский союз пекарей
Лариса Кузнецова
Александр Калинин
Максим Курганский
Олег Павлов
Общественная потребительская инициатива
Болгария
ВинЛаб
Fresh Lab
Игорь Чебунин
Сергей Сухоруков
Ольга Проскурякова
Лариса Романовская
Эдуард Уткин
Михаил Несветайло
Ассоциация Гильдия ювелиров России
Арт-КАРАТ
LCI Partner
Ольга Злотя
Оптимум Сток
Malivar
самовывоз
Максим Булычев
товары для здоровья
Александр Митюков
Межрегиональная ассоциация курьерских служб
ТЦ Неглинная Галерея
PNK Парк Ростов-на-Дону
Рим
Прямиком
Master Delivery
Станислав Колосков
Антон Куканов
Street Food
Иван Щербаков
Виталий Степин
Владимир Пинаев
Екатерина Петрова
Олеся Машкина
Александр Колобов
Гипфель
Российский экологический оператор
Российский книжный союз
Мария Филиппова
Дмитрий Досько
Nelumbo market
ТЦ Голубое
Ирвин
Тамерлан
Белуга Маркет
тимбилдинг
СберНПФ
кондиционеры
Государственная информационная система промышленности
ГИСП
Здравсити
Александр Филиппов
Яна Андреева
Старый Арбат
НПП «Спецтехномаш»
Александр Князев
Гознак
Акфен
Crave
Gardenica
Flomni
Ольга Казначеева
Станислав Полубинский
IFORS Research
Restocker
Алексей Мамонько
Сергей Кичагин
Игорь Головко
Наталия Киреева
возобновляемая энергия
Rockefeller Foundations
Фарид Камалов
Контур.Призма
MALLTECH
Лоран Дефассье
Oculus
Марат Арсланов
Авито Подработка
Анна Ошарова
«Ярче!»
REBR
Артур Саркисян
Александр Ставцев
WineRetail
электронная подпись
Марина Лаговская
Moby
Wheelys
Hive Box
Алексей Музеев
Solar Staff
Павел Шинкаренко
Правовая команда
Leica Leitz Phone 1
Leica
кошерные продукты
халяльные продукты
суши-поинт
Михаил Конев
POPAI RUSSIA
Selfridges
Андрей Патока
CARBOMA «Блисс»
ГК «Полаир»
Dsight
Psychea
Борис Преображенский
ПрактикаDays
Игорь Колынин
Skillaz
Андрей Крылов
Цвет диванов
Pernod Ricard
растениеводство
Русмолко
Велком
Останкино
Алексей Груздев
Андрей Губка
Евгения Мельникова
Point Estate
BOSS
мировое соглашение
Трикотаж Групп
виртуальный помощник
RAUM Бугры
Guinot
«Алоэ»
Роснефть
ПОЛАИР
Павел Кейнис
Дмитрий Селихов
PicsArt
Андрей Васин
Салатерия
SHEBA
Институт цвета Pantone
Денис Блинов
Яна Белова
Mesto
Иван Мельник
Xbox Mini Fridge
Xbox
Минприроды
запрет на массовые мероприятия
ПЭТ
Collaborative Ads
детские коляски
Facebook live
Андрей Новиков
Starfish
Артем Спорыхин
кокошники
Екатерина Трофимова
Verme WFM
Perfetti Van Melle
разрыв контракта
Salamander & friends
Анна Лиханова
Хороший мини
Никита Чугунов
Алена Бочарова
Владислав Земский
Белпочта
Денис Кузин
хоккей
шоколадный пломбир
распознавание эмоций
Центральный телеграф
многоразовая посуда
осознанное потребление
биоразлагаемая посуда
Ян Витров
Дмитрий Богод
закрытие ТЦ
сортировка упаковки
Истра
Место встречи София
Сергей Коротков
Choice Hotels
GolfNow
Google Pay
Sber Pay
Всегда.Да
Артем Борисов
Ацино Рус
Денис Глядяев
Nika Watches
Vivienne Sabo
Сервисы для Екома
Frisbuy
Дмитрий Зинько
Собиратор
потребительские расходы
Анна Щепилова
iPadOS 15
iOS 15
онлайн-обучение
iSpring
Алла Бедненко
Brainstorm.fm
Константин Колосков
Владимир Булавин
Михаил Дубин
UEFA EURO 2020
уйгуры
Алексей Новиков
Лига зеленых брендов
платежная система «Мир»
Томская область
Самсон Фарма
доля в капитале компании
капитал компании
кредитный брокер
X5 Group
новогодние каникулы
Webinar Group
Александр Альперн
Desserto
Алексей Малиновский
Илья Кретов
Михаил Толоконников
Ассоциация Производителей Альтернативных Пищевых Продуктов
Вячеслав Бочаров
Владимир Ефимов
Symfonisk
GFG
ПМЭФ
новые продукты
Дедовск
SF.RU
Никита Шабашкевич
Вероника Никиншина
Андрей Писарев
Андрей Осокин
Puig
БИО ПЛАНЕТА
PLA
Илья Шалыгин
Кристиан Мората
Павел Томанек
Дмитрий Масюк
Дербент
российский ритейл
накопления
IMPERATOR-FORUM 2021
Ingate
Василий Дроздов
Wegmans Food Market
Олег Дорожок
Эвотор.PAY
Ваэ Овасапян
Burton’s Biscuit Company
социальное предпринимательство
единая онлайн-платформа
Global Entrepreneurship Monitor
F+ pro
«Марвел-Дистрибуция»
квадроциклы
MiNiMi
Philippe Matignon
Filodoro
SiSi
OMSA
Golden Lady
Бухонлайн
Елена Маврицкая
Денис Юрасов
байер
Елена Мишукова
myToys
Аби
непрофильные товары
Orbit Refreshers
имиджевая кампания
Эндрю Костман
Helium-10000
автокресло
покупка бизнеса
Mamsy
ритейл
временный персонал
MyGig
Кардашьян
фейковый сайт
пиццерия
Сергей Лисовский
ТЦ Сибирский городок
ТРЦ Июнь
День защиты детей
Антон Борисов
Мултон
одноразовая посуда
обезличенная упаковка
закрытие сети
Неймар
Видеомаркетинг
Logaster
Игорь Волков
Мишкино
Регина фон Флемминг
Ваби Саби
Fuchsia
SberAutoTech
ФЛИП
электротакси
«Южные Врата»
PIM-каталог
Место встречи Саяны
Witt
Quelle
Наталья Патрунина
Точка Роста
Истра-Нутриция
Елена Суховей
НЛМК
Олег Акчурин
Плодоовощной союз
товары легкой промышленности
Александр Митурич
товары российского производства
уровень счастья
trendHERO
Андрей Калашник
Businessmens.ru
Юрий Богомолов
HarmonyOS
Ehrmann
FrieslandCampina
KPI для продавцов
EGGSELLENT
Vindome
Playkey
Почта Киргизии
курьерская служба
Outlet Village Vnukovо
День предпринимателя
срок службы
гарантия
свадебные платья
гастрономия
линейный персонал
АПТПРР
RT-Mart
Александр Хинштейн
Нетология
Via.Delivery
Hupan
крем от солнца
эко-коллекция
водонагреватели
IT в ритейле
Redenex
одежда для последнего звонка
последний звонок
Онлайнтрейд
Светлана Ольшанская
Level Kitchen
Justfood
Шефмаркет
SaveTime
Tinkoff Data
Meeting point
Marketing jobs
РГС Банк
Владимир Морозов
Геленджик
Артём Белов
Озон Кредит
поколение Z
социальные гарантии
ByteDance
российские продавцы
стоимость обработки от клеща
клещ
смена фамилии
IPLS 2021
Оксана Луговая
УТП
Ася Тихомолова
Happy Returns
Екатерина Мыслицкая
Zeekit
Татьяна Трифонова
Зеленый ритейл
Сергей Студенников
велопатруль
Vanderlande
поп ит
симпл димпл
Алексей Гребенюк
Кирилл Терещенко
Сергей Беляков
Станислав Черчесов
РФС
Сергей Ли
Геннадий Бравве
Сергей Швецов
REWE
GetFaster.IO
эконом-сегмент
гранты
Рамиль Сулейманов
Жизньмарт
Сергей Третьяков
Дмитрий Патрушев
Александр Шульгин
арт-объект
«Veer Mall»
фермерские продукты
«Ешь Деревенское»
спортивное питание
диетические продукты
учет рабочего времени
Центр RCB&B
Николас Коро
Четвёртый Рим
SamsungPay
Кэндзо Такада
Союзроссахар
МЕГА Химки
CityNature
Damat-Tween
отрасль ритейла
Солнцево
ТРЦ Небо
JoomPro
КрасоткаПро
Москва Медика
Стратегический партнёр
Авто-тюнинг24
Медтехника+
Dostavista
Tefal
Андрей Медведев
Transcript
Василий Менцик
Хачатур Помбухчан
ЭкоХлеб
индекс Иванова
корюшка
ГК Новард
Сергей Саркисов
мобильный маркетинг
Rakuten Viber
Кристина Констандаке
JPL Telecom
Дмитрий Архипов
GLOBAL EVENTEX AWARDS
Colbeck Capital
Алина Юхневич
Детмир
Джордж Клуни
Егорьевск
CROCS URBAN
новый продукт
рынок «Садовод»
Osnova
Каберне Совиньон
Naumen
популярность
Foodbasket
Михаил Свободин
SAP CIS
Андрей Горяйнов
CHEP
Андрей Писарцов
Агроэкспорт
Houzz
Panera Bread
Tommy Jeans
PHYGITALISM
Егор Жаворонков
Аника Керимова
Upfield
RAMA
Scotch & Soda
ОАО «Синтез»
BioMio
Kontakt InterSearch Russia
Марина Тарнопольская
Клименченко Мария
Digital G
социальный бизнес
Реваз Юсупов
Harley-Davidson
фирменное наименование
смена концепции
портативные колонки
Acoola
part-time
Евгений Коночкин
Сергей Павлов
Леврана
ЦЕХ85
Паскаль Брюн
Ольга Чернявская
Конституционный суд
Kroger
Сергей Михайлов
Russian Hackers
шашлык
сырники
АО «Марка»
кагор
OralB
Braun
СДЕК
НТВ+
Get4Click
Артур Ромашин
Евгений Чечёткин
Антон Максименко
Кирилл Горыня
Анастасия Панина
Евразийский пивоваренный альянс
Ассоциация производителей пива
банк «Акрополь»
Effie Awards Russia 2021
Константин Пономарев
Фокстрот
Евгений Кречетович
eSputnik
Шудрик Валерия
Хром
Григорий Хромов
Food Rocket
Cappasity
Виктория Андреянова
Максим Ползиков
ТРЦ Мозайка
Маргарита Молодых
Илья Лагутенко
Станислав Чернин
юбилейный магазин
майские праздники
поисковик
International Digital Retail Forum
Юрий Шишкин
SKIBIDI
MegaMeeting 2021
ткани
One Bucks Coffee
средний бизнес
Станислав Жураковский
Greensight
Best2Pay
Кирилл Салов
Роман Тихонов
Илья Летунов
Оксана Щирба
Роман Варник
Андрей Ревяшко
Павел Щербинин
IPG.Estate
Агуша
украшения
ТРК Мурманск Молл
Tezenis
Чек Индекс
пасхальный набор
Пасха
СберМегаМаркет
снятие наличных
Manzana Group
Олег Паленов
Тимур Зайцев
Домашкино
Gurtam
ЕГРЮЛ
объединение компаний
Отдохни
ОКБ
мангал
Poster
Елена Степанова
Полина Большакова
RETAIL WEEK AWARDS
Денис Скоков
Светлана Можаева
Фестиваль тюльпанов
ликер
Магнит Мастер
Lenovo K12 Pro
возвращение на рынок РФ
велоинфраструктура
iPhone 13 mini
социально значимые продукты
социально значимые товары
FinExpertiza
Авито Услуги
Ирина Архипова
командировки
Insider
многоканальность
Scallium
Андрей Павленко
Дмитрий Логинов
Сакен Багаев
Lululemon
Виктор Захаров
Максим Бахтин
Инна Караева
Иван Котов
Pangaia
СберМузыка
фудтрак
голосовые сервисы
Неделя Ритейла 2021
IDRF
themarket
WantHerDress
Саид Мунаев
Ситроникс
Haier
стриминговый сервис
Muzlab
Yandex.Cloud
Павел Голубин
профессиональное выгорание
Алекс Штейнгардт
Innovating Prof Beauty
Сергей Слащилин
Алан Гацолаев
Curb Mobility
ТРЦ Зеленопарк
Зеленоград
Superapteka.ru
Миндаль
TikTok-хаус XO Team
ресторана «Прага»
Wainbridge
Александр Миронов
Hotmaps
Андрей Гнелицкий
МакАвто
Ubirator
садовый центр
ТВК «Калейдоскоп»
ТРЦ Планета
«Продэкспо»
iNST Group
ТРЦ MOZAIKA
АСПП
Ассоциация сетевых предприятий питания
Vprok.ru Перекрёсток
Сочинский мясокомбинат
Симбат
DELTA LI-ION
Сергей Фурсов
Ingka Group
MUD Jeans
набор специалистов
штат
IT-специалисты
самокаты
KDV
ИНПАС КОМПАНИ
Илья Карпейкин,
D2C
Mars Wrigley Россия
ZDHC
ТЦ «На Беговой»
портрет покупателя
ТД «Мое Лето»
свежесть продукции
фитнес-браслеты
RDV Market
ритейл-парк
Data Fusion
Дмитрий Берестнев
Kuehne+Nagel
бондовые склады
ТЦ GoodZone
аффилиатная платформа
банковская лицензия
День космонавтики
«Много лосося»
DreamWhite
Дарья Денали
перепродажа
FBS
Тайланд
РВК
кетчуп
майонез
доставка продуктов
Артур Саркисов
Дмитрий Пучков
Warner Brothers
Гарри Поттер
условия работы
QIWI Business
Русская рыбная компания
торговая площадь
Effie Awards 2021
Лев Пархоменко
Авокадо
шоплифтеры
Делетрон
Евгений Золотарев
Solstudio Textile Design
АИДТ
ТЦ «Шоколад»
Жуковский
National Geographic
Алексей Мордашов
спиртные напитки
Валта Пет Продактс
Людмила Ващенко
Google Workspace
Владислав Алмазов
Никита Джигурда
туалетная бумага
LCM Consulting
ТРЦ Соломбала Молл
Поморье
функция Payments
пожертвования
Nikon
МИЛКОМ
ОптимумСток
Хэдлайн-Трейд
Иван Бабушкин
Ингольф Браун
Janie and Jack
корпоративное управление
пункт приема товаров
ПРОДЭКСПО-2021
Квант
Артель
Елена Ипполитова
Aplaut
Станислав Бай
ZenScreen MB16ACV
СберСпасибо
запрет продаж
основное меню
ароматизаторы
красители
защитный гель для рук
единый налоговый платёж
Apteka.ru
озеленение
превышение полномочий
праноеды
прана
Grow Food
GoOMNI
1 апреля
бизнес
Красная машина
TOY.ru
Fashion Baby XYZ
Наталья Водянова
совет предпринимателей
джем
виртуальная одежда
цифровая мода
Евгений Мовчан
Fortum
Sarafan Technology
RUSH
Сentric Software
Lil Nas X
Андрей Протопопов
Сергей Солонин
Борис Ким
Garnier
пляж
Черное море
гипермолл
Олег Альхамов
Уссурийск
Виталий Бедарев
клиентская поддержка
DIY RETAIL RUSSIA TOP
экосбор
MySizeID Russia
Тамари Миминишвили
Sizolution
Станислав Подшивалов
Методиева Илона
Касперский
Екатерина Логинова
Суэцкий канал
контейнеровоз
Shikkosa
товары собственного производства
Выборгский завод холодильной техники
MY.GAMES
видеоигры
Чистая линия
ТРЦ Ривьера
ECCO Kids
Rubbles
Perfluence
Кирилл Пыжов
Лама
Радио Disney
Яндекс Музыка
смена профессии
тикер
Михаил Морозов
Евгения Хакбердиева
Леонид Аникин
День качества
Helly Hansen
кабачковая икра
паралимпийцы
Австрия
металлоискатели
Аман Тулеев
ключевая ставка
работники торговли
ТЦ «Космопорт»
ТРК КомсоМОЛЛ
коллективный иск
BIOSMART
Александр Дремин
профессиональная репутация
Discord
Великий Пост
ТЦ «Парк Хаус»
СберПодбор
Upmarket
Максим Шелуханов
отдел продаж
Мария Зивтинь
«Самбери»
Оkko
KIVI
SELFIE2PAY
Внуково
Агрокомплекс Ткачева
Юрий Годына
УК «Столица Менеджмент»
Ольга Летютина
SmartEstateMoscow
совместные покупки
троян
Яндекс.Услуги
PLM
итоги 2020 года
Роман Скороходов
Мария Вакатова
iNDEX
Антон Баринов
Shu Uemura
цифровой оффер
отравление продуктов
День инвестора
загрузки
Михаил Никифоровский
СБИС
Астрал.ОФД
OFD.RU
операторы фискальных данных
MAGRAM Market Research
АКРА
подделка
семена
Ассоциация больших данных
большие данные
PNK Парк Жуковский
NESCAFÉ
дропшипинг
Евгений Бахарев
MIUZ Diamonds
Вячеслав Зайцев
Эмманюэль Фабер
вишневый сок
Роскартография
Иван Есев
Анастасия Кадыркина
Анастасия Грашкина
Standard Cognition
Fort Ross Ventures
ПО
Минцифры
Hello Foody
бодипозитив
Бизнес-батл
Digital Voice
Simone Rocha
Аллахверди Абдуллаев
домашний арест
почтомат
KR Properties
Marc O'Polo
Анастасия Большова
Вадим Федотов
Selectel
Камилла Шин
Николай Перевоз
Retail TECH
Yandex Pay
Петр Середкин
Артур Серопян
email-рассылка
Siberian Wellness
Светлана Золотар
ТРЦ Гринвич
акция
KazanExpress
вокзалы
Аллахверди Абдулаев
Росптицесоюз
оплата взглядом
Олеся Елина
Кирилл Шпара
АКСОН
выкуп
Exor
Fiat
блинница
Мультимаркет
блины с мясом
мусор
Merlion
Александр Петрунин
Алексей Касимов
Тинькофф Бизнес
Jordan
корпоративный кампус
Jil Sander
Umalat
блины
Масленица
Disney Store
The Walt Disney
горячая линия
Amazon Go
МЕГА Теплый Стан
Сергей Парфенов
Юлия Никитина
Борис Овчинников
ОнлайнЦентр
Никита Кочергин
QN Europe
Жером Хоэрт
Дима Билан
ТЦ «Макси»
ГАЗель
Риэлти
Эдуард Эйдлин
DOM
Никита Шмаков
Продвей
Сергей Копылов
Vorsh
Сергей Семенов
Строительный двор
перепись
Траст Групп
Геннадий Ахмедов
K50
Petshop.ru
Санта Бремор
Retail Today
оливковое масло
Олег Куликов
клип
Моргенштерн
Daft Punk
Сергей Катырин
Владимир Шмойлов
Тамари Миминошвили
Игорь Татаренко
Никита Гарайев
прием вторсырья
бытовые отходы
Петрозаводск
Agent Provocateur
хлебобулочные изделия
Пятёрочка Доставка
межгосударственный розыск
эко-товары
ГК «А101»
Bringston
Валентин Куликов
The Ordinary
Schneider Electric
VK Работа
Inventive Toys
Олег Дерипаска
Роспечать
SAS Retail & CPG Practice
Джессика Кертис
ClubHouse
iPhone 13 Pro
ГК «Экоофис»
гендерные праздники
Александр Гудков
Леонид Гольдорт
Кузьминки
регистрация бизнеса
Business ID
сеть аптек 36,6
конвертируемые бонды
Оксана Колесникова
RTB House
Алексей Хижов
супервайзер
Забайкальский край
Некрасовка
технический регламент
продукты без глютена
полиэстер
Ирина Зильберберг
Александр Барсуков
Филипп Лабковский
techwear
логистический хаб
Mercedes-Benz Fashion Week Russia
начальство
Николай Абу-Ржейли
Янина Князева
Святослав Бирюлин
правила потребителя
ТРЦ Матрица
Coop Italy
Coop
QNET
гендерные различия
Михаил Ярцев
REES46
Михаил Кечинов
ГК «Орион»
Яна Гладышева
USM
ООО «Банк Стандарт-кредит»
этикетка
взрыв
Владикавказ
CloudContent
Дмитрий Безруков
Kokoc Group
Евгений Моисеев
UPGRADE
Любовь Кононова
бумажная бутылка
Арсен Каноков
«Синдика»
Москворецкий рынок
Kenzoki
полезные батончики
БашМаг
Александр Козаржевский
Федор Вирин
Надежда Цветкова
RetailNext
Birkenstock
памятник онлайн-покупкам
Rose Group
Bonum Capital
уязвимость
Hilti
пилотные проекты
Леонид Нагайцев
ВиРент
Павел Иванов
Calltouch
Павел Мрыкин
Дмитрий Алексеев
итоги работы
ценовая категория
NBA
Ольга Кукушкина
Macroscope Consulting
Out of Cloud
Антон Самутин
Екатерина Пряникова
товары для науки
ТРЦ Павелецкая Плаза
Mall Management Group
The Outlet Moscow Архангельское
Сергей Галеев
«Остров Мечты»
микробиологическая лаборатория
Светофор
Mere
TanukiFamily
комиксы
панно
реставрация
Деликатеска.ру
GetResponse
бананы
пестициды
Stokke
LA VIVION
Андрей Янчевский
Repina branding
Валерия Репина
Brand Analytics
ПИК
водитель-курьер
Extyl
Олег Громов
Neti
Наби Ибатулин
сортировочный центр
Hays
Везёт
Елена Матвеева
Stream Expert
Ольга Турчина
Заполярье
кассы
Алексей Фурсин
успокоительные препараты
преступления
малый формат
Анна Саливон
Dalli
анализ данных
ThoughtSpot
иностранные компании
клюквенный морс
Фотосклад.ру
Алексей Банников
Chaokoh
обезьяны
бойкот
День святого Валентина
Алексей Быченок
JMART
3D-принтеры
моногорода
мобильные операторы
Линия
Корпорация ГРИНН
Виктор Гридасов
Luxēmporium
вода для кулеров
Outfit
Evans
Miss Selfridge
Wallis
Burton
Topman
Retail Trust
Oasis
Coast
MissPap
PrettyLittleThing
Boohoo Group
Home & Services
Ольга Паршикова
налоговый вычет
вкусовые предпочтения
Сушкоф и Дель Песто
Михаил Кольцов
Евгений Плющенко
Яна Рудковская
Гном-Гномыч
товары для блогинга
блогинг
кассовый чек
запчасти для мебели
Поинт
айдентика
кишечная палочка
плесень
пряности
телефонные звонки
Fjord Plaza
мягкая упаковка
DropCat
push-уведомления
Skyeng
Duolingo
Анастасия Долгова
Счетная палата РФ
Светлана Демяшкевич
одежда напрокат
тренды потребления
журналисты
Pressfeed
Мария Соловьёва
Владимир Кошмар
ответственное потребление
Сергей Зуев
обвинение
самоуправство
ТилТех Капитал
Редиска
Вадим Филатов
ветеринарный кабинет
автодилер
антистресс-товары
NCR
Монополия
FELIKSOV DIAMONDS
Хакасия
АПК
Владимир Веселов
Google Ads
коллтрекинг
Гудок
Иван Шкиря
Жерар Депардье
Violeta by Mango
Violeta
обогреватель
AppGallery
российские товары
правила торговли
ТК Три кита
Артур Мазлоев
Tabasco
Rademar
Кировская область
РЦ Будапешт
Ozon Express
Альтфина
Елена Райтс
строительные материалы
Fast Retailing
Павел Воля
Ляйсан Утяшева
VOLЯ WEAR
антиковидный паспорт
якорный арендатор
виртуальная подарочная карта
Ли Чжэ Ён
взяточничество
тюремный срок
товары для умного дома
Salamander
органические продукты
Ростелеком-Солар
Okdesk
Кирилл Федулов
малые города
дебетовые карты
ГК Киевская площадь
вакцинация
ЛизаАлерт
островок безопасности
Пентагон
СДЭК-Глобал
злоупотребление положением
творог
нейросеть
Mindbox
Сергей Юдин
ТЦ Город
SAIC
гибридный режим занятости
SRV
Саранск
Sinsay
ivi
КиноПоиск
Тинькофф Инвестиции
Кактус
Виктория Кучинова
досудебное обжалование
Couche-Tard
SAS
национализация
банковская тайна
МакДоставка
робот-уборщик
live commerce
ShopStory.live
Мариам Палян
Крис Хемсворт
Лондонская биржа
Dr. Martens
Патрик Антони
МЕГА Белая дача
ЮMoney
Jaeger
Marks & Spencer
Йоханнес Толай
Relog
пожарная безопасность
курительные смеси
Михаил Каплун
Прибалтика
H.A. Brieger
Dzintars
Pull & Bear
лыжи
коньки
кофейные автоматы
СмартБуфет
MAERSK
киберграмотность
Илон Маск
Digital Fashion Lounge
FAGE
Анатолий Дроздов
Thomas Munz RUS
Магазин 4.0
Антон Коробков
Андрей Павлов
Patagonia
Intellpack
эко-френдли
гринвошинг
Игра слов
Екатерина Макарова
Tiu.ru
Пьер Карден
Александра Артюшкина
Pierre Fabre Group
Vassa&Co
Наталья Райш
ЛЭНД
SberDevices
Елена Жабинская
переход в онлайн
Михаил Костромин
ICQ New
Uchi.Ru
Local Kitchen
Rakamaka fit
Макдоналдс
Juicy Fruit
Бон Пари
Dirol
Cheetos
график работы
ЯНАО
Салехард
Небесный Дракон
Александр Низник
Сomme des Garsons
Анна Баландина
Пульс
ЛАВСИТ
Медиасфера
Тимур Угулава
VALDAI NEXT
Игорь Сосин
торговый зал
HSBC
Дмитрий Красилов
CITIC Telecom CPC
Ewave Europe
Артём Елизаров
Pangeya
Владимир Елькин
Samsung Galaxy A51
Александр Исаевич
Росаккредитация
вегетарианский оливье
Татьяна Глазачева
Юлия Шатилова
Андрей Крупский
Ураса Молл
Якутск
товары для фермерства
Иван Семягин
Татьяна Шпакова
Verria Chocolate
Vermonaginger
Terracota plants
Podarki Forte
Flowwow
Андрей Макеев
Сергей Чиграков
Дина Лаврикова
Банк Точка
игристое вино
Андрей Трубников
Briskly
Вероника Климова
фаст-гурмэ
Наталья Привалова
документальный фильм
система поощрений
TIPS
Юрий Ткачев
ТЦ Охотный ряд
торговая наценка
Александр Лебедев
Всероссийское общество глухих
Вячеслав Заяц
ХлебСоль
дистрибьюторы
Inventive eCommerce
Евгений Усенко
L’Occitane
Data Driven Agency E-Promo
Полина Краевская
S.Friday Socks
SELA moms & monsters
Cyberpunk 2077
Cyberpunk
АО «ПАО «Массандра»
банк «Россия»
искусственная елка
Фонд Константина Хабенского
Константин Хабенский
ТРК Кварц
«Калина»
Михаил Муллакандов
Эндрю Торре
зимние террасы
Институт региональных проблем
Maison Tamboite
доступная среда
Victoria Beckham at Home
геоаналитика
digital store
фандомат
новогодние украшения
Давид Манзини
Business Intelligence
GlowByte Consulting
Екатерина Благирева
Google Meet
CP Retail Development Company
сериал
Четыре лапы
томаты
яблоки
Магнитогорск
BrandMonitor
оливье
парогенератор
Эван Барлоу
Mercury Media Group
Николай Ермаков
Свеза
зеленая продукция
Чиж & Co
ЮНКТАД
Яндекс.Ровер
Коммунарка
UrbanTiger
Щелкунчик и Мышиный король
Korzinka.uz
Addreality
Лина Архипова
лотерейные билеты
Столото
Русопрос
инклюзивность
зубная паста
Тильзитер
выбор профессии
UXSSR
зимняя одежда
экспорт
Jam Agency
елочные игрушки
Нижневартовск
Stone Island
Роллтон
говядина
Atlas Delivery
Дмитрий Серажим
Федерация хоккея России
СберИндекс
Донер 42
донер-кафе
сеть донерных
Dodo Brands
ЭвоКарго
Бутово
вторсырье
Pringles
UD Group
Жулебино
фудмолл Привоз
фудмолл
ГК Император
Oberon
Максим Мечиков
День матери
Montblanc
CDNvideo
Новая Зеландия
сокращенная рабочая неделя
инвалидность
люди с ограниченными возможностями
популярные категории
автозаправочная станция
ОАТИ
видовая подмена
печень трески
социальные проекты
Ася Вильдт
Eat Just
Good Meat
Одинцовская кондитерская фабрика
ГК ЭкоТехнологии
ПЭТ-коррексы
рецептура
бургеры
RS No. 9 Carnaby
Rolling Stones
SBTi
верхняя одежда
дубленки
FriFlex
Петр Чернышев
Игорь Рожков
ТЦ Гравитация
адвент-календарь
пихта Фразера
торгово-холодильное оборудование
Brandford
Dorothy Perkins
Arcadia Group
прием платежей
IntellectMoney
красная рыба
елка
RBK.money
Денис Бурлаков
Максим Карбасникофф
совместная коллекция
MARVEL
Лаборатории Касперского
Ростагрокомплекс
Борис Александров
Алексей Федоров
магазин-склад
AERO
редизайн
Антон Титов
позиционирование
OR GROUP
диджитал-реклама
Васильева Алла
American Eagle
Urban Outfitters
Good Vibes Juice Co
Nintendo
PlayStation
Алексей Киричек
PlayStation 5
Рустам Минниханов
Мартин Уотерс
Lamoda Planet
экологичность
Павел Волокитин
Кирилл Фомичев
Артем Бобцов
Максим Удодов
Павел Орлов
Владимир Горбунов
приложение Город
Trendfox
Мила Кретова
Дмитрий Махонин
Марсиаль Роллан
KitKat
RNC Pharma
Вячеслав Вишневский
снижение доходов
Денис Сологуб
стрит-фуд
Lao Lee
Леонид Пятильройд
Ives Rocher
Dirty Lemon
Hills Pet Nutrition
Металлопрофиль
кондитерская фабрика Победа
ОМК
Северсталь
Вячеслав Коган
Petroglyph
MOJO Cacao
TUC
Медвежонок Барни
Юбилейное
Picnic
Alpen Gold
Riso Scotti
Green Milk
Nemoloko
Александра Гудимова
Ольга Жукова
умная колонка
Станция Макс
гигиенические товары
Яндекс.Заправки
L Brands
Александр Лифинцев
фоторепортаж
Deli
Павел Трубецков
CS-Cart
электронные перевозочные документы
Зарплата.ру
myTarget
Foody
лучший работодатель
Зорька и Милка
Константин Пинигин
LEGAL to BUSINESS
Дарья Филина
Наша Птичка
Группа агропредприятий Ресурс
Ирина Климова
Stylus
НДФЛ
Эксперт РА
электронные чаевые
детские смеси
Евгений Горцев
диджитал инструменты
PRNEWS.IO
Ксения Резникова
Лига Цифровой Экономики
Николай Яковлев
c2c
Luxxy
Elementaree
Дмитровский завод РТИ
REVIEW3
Михаил Егоркин
сбор ненужной одежды
ХАЯТ Россия
Domestos
Play Station 5
Дамате
Artics Internet Solutions
Мария Самойлова
Елена Шутюк
Ленточка
поддержим врачей
Место встречи
Тетрон
Optym
Леонид Кушнир
Александр Бугаков
Артур Гулян
инструкция
ужасные рекламные ролики
польза и вред продуктов
Osteria Mario
ready-to-cook
Оксана Любивая
работа с данными
Veritas
Всемирный день шопинга
Dyson
Ventra
Юлия Бабинская
краудлендинг
ПВЗ Детмир
Юки Кусуми
автозапчасти
авиакомпания Волга-Днепр
аварийная посадка
Юрий Гагарин
Поехали!
хурма
iPhone Pro Max
iPhone mini
персонализированное предложение
антидепрессант
StormWall
DDoS-атаки
E-Promo
Алина Фомина
R2 Asset Management
Алекс Фридланд
Ventra Go!
Эдвин Луканов
Сервис Дистанционной Торговли
ТРЦ FORUM
Gruppo Teddy
круглосуточные магазины
налоговые каникулы
METRO Chef
WhatsApp Business
Виктор Евтухов
кейтеринг
Владимир Самохвалов
продавец-консультант
Наталья Щербакова
Каспер Рорштед
Андрей Романенко
кибербуллинг
хайбургер
Вячеслав Финаков
Зелёный день
комплектование заказа
Pick-by-Voice
голосовой ассистент
Art Nation Loyalty
АТБ-маркет
Segmento
Дринкит
GastroReview
СберФуд
Restoclub
GetTable
TripAdvisor
Fibbee
Александр Хвастунов
Digital China
Tinkoff Pro
Илья Саттаров
Globaltruck
Зелёная линия
расторжение контракта
Алибокс
Около
агрегатор доставки
продовольственные карточки
IHS Markit
сельхозпроизводители
Restoration Hardware
Teleperformance Russia Group
Анна Ставнийчук
сайты объявлений
Игорь Артемьев
Хейго Кера
глобальные депозитарные расписки
котомем
WHISKAS
Дмитров
Михаил Кучмент
СберУслуги
сенсорные кассы
Неделя ритейла-2020
Ecom Retail Week
генеральный партнер
продукты первой необходимости
Иван Буторин
Love is...
585 Золотой
Алексей Феликсов
распродажа
Алсу
Fortune
Canalys
Hi
Novex
Игорь Коропов
Ирина Бахтина
Фонд Антон тут рядом
Twitch
планёрки
универсам
El Corte Ingles
дегустационная кухня
Скрепыши2
Instamart
Cerebelly
Cyber
Елена Шифрина
сокращение штата
Дэниэл Чжан
листинг
КООП Маркет
потребительский кооператив
Георгий Аликошвили
Фабиан Шефер
SberPay
ТЦ Ереван Плаза
Мясновъ
Мама Карелия
Григорий Щёголев
Александра Сухарева
Ольга Караева
Антон Афанасьев
Лиза Алерт
пропажа
Skillbox
Игорь Кропов
Дмитрий Андреев
Škoda Kodiaq
VF Corporation
VF
А3 Retail Group
Inspire Brands
Inspire
Mac
NASDAQ
Zebra Technologies
ШТРИХ-М
Пётр Казорин
Юрий Соловьев
инвентаризация
Антон Буздалин
решения для торговли
Треснутые
Магнит Доставка
Вячеслав Иващенко
Александр Усс
Хабр Карьера
Полина Жилкина
Вкус жизни
Floor Service
Стратегия
Лемчик, Крупский и партнеры
Атланты
Траст Групп БТЛ
Карина Малюкова
SkyNet Retail
СТЦ
Армин Бургер
просрочка и списания
антиреклама
функциональное питание
NL International
Александр Манцуров
холдинг Сибирский гигант
Биннофарм Групп
запрет на курение кальянов в ресторанах
Юрий Владыкин
робот-официант
Воронежская область
Аня Reira
Анна Протасова
клиентский путь
Дмитрий Смирнов
Performance Group
Госкомиссия
Максим Протасов
Тигран Худавердян
социальный эксперимент
фаббинг
VK Pay
Денис Шерстенников
Ларс Леманн
d365commerce
онлайн-покупки
Анастасия Меркулова
Андрей Кришнев
Россельхозбанк
брокеридж
RealJet
универмаг Московский
Realme
OPTIMA Development
PRAKTIKA group
Булат Шакиров
Ирена Понарошку
премиальные товары
Magnit Pay
Соколоверов Александр
ГУД-ФУД
Владимир Салахутдинов
Санта-Клаус
AppStore
«Нева»
Профессиональный Ресторанный Альянс
грибы шиитаке
PIM.Tracking
Нукри Башарули
Всеволод Вайнер
Gamages
Pauldens
Dickins & Jones
Peter Robinson
Bourne & Hollingsworth
КОРУС Консалтинг
результаты работы
ипотека
Shopping Live
Taxi
TVOЯ
Дэнни Перекальски
Shine Is
Дмитрий Гришин
отказ от проекта
ПВЗ
Наталья Плетнева
Waitrose
Made.com
касса
прививка от гриппа
Пятёрочка налету
ТРК Гравитация
eSIM-карты
витамины
Mojang Synergies AB
карты Таро
ВЭБ.РФ
макаронные изделия
СБЕР ЕАПТЕКА
зумеры
Кабарга
Галина Харнахоева
Retail Rocket
Виктор Зырянов
трансграничная торговля
Волгоградская область
Карта Бургер-Кинг Тинькофф
российские бренды
Александр Беглов
Goods House
Cook House
ТК «Невский Центр»
FreshEcoFood
порошок
Леонид Маркелов
Марий-Эл
Prime
Камила Кадырова
Игор Раич
Евгений Пажитнов
Александр Голубев
Вячеслав Денисов
Смольный
Сундар Пичаи
книжная премия
приложение Razz
направление бизнеса
финтех
iPhone 12 Pro
сторис
Starbucks® Delivers
Семья
Наталья Костина
Екатерина Евдокимова
R.M. Williams
IKEA Family
Аномалия
Ozon.Invest
МТС Банк
Федерация рестораторов и отельеров России
школа для предпринимателей
кобрендовая карта
Модульбанк
Mr. Doors
Алёнка
Борис Кац
Сергей Васин
товары для хобби
налог на роскошь
продукты с повышенным содержанием сахара
сладости
Goldman Sachs
Baring Vostok
Tishinka Gastro Hall
ТРЦ ГРОЗНЫЙ МОЛЛ
локдаун
Борис Добродеев
Максим Акимов
учителя
Мария Давыдова
реформа
издатели
периодика
карточка товара
Дмитрий Лазарев
Даниил Матвеев
машинное обучение
Юлия Порохненко
онлайн-продажа лекарств
творожные сырки
день рождения бренда
Ассоциация торгового маркетинга
ваучеры
BuyBackFriday
Admitad
Сравни.ру
Карлос Альберини
Симон Бахчинян
сертификация
бизнес-класс
авиакомпания
Finnair
TCS Group
Эмануэль Унгаро
Emanuel Ungaro Home
Ungaro Home
киберспорт
товары для гейминга
Lefties
JTBD
бизнес-игры
Marketizzy
Яна Османова
ТЦ «Черемушки»
Норберт Степновски
vprok.ru
фулфилмент-фабрика
ТЦ «Европа»
Бен Горхэм
Byredo
ароматические свечи
видеосервис
Netflix
складская недвижимость
Hotpoint
TWIN
Игорь Калинин
Iceland
сбор батареек
Нигерия
Zeytz
Кирилл Кириллов
Анна Попова
Memphis Meats
растительное молоко
GenerationS
Красная линия
Довгань
задержание
ПРОСТОР
Яблоков
Hemp Bang
ТомТом
Сташевское Био
ПРИНТО
Frais
Константин Земсков
Тинькофф Оплата
Слата
готовый бизнес
PRonline
MD Audit
Андрей Подгорнов
Яндекс.Драйв
квас «Лидский»
App Annie
сливочное масло
возврат билетов
билеты
экоигрушки
FASHOUSE
Facemetric
Екатерина Дмитриева
MediaGuru
Александр Ярощук
спортивная одежда
Forward
умная техника
Desigual
Joki Joya
Maleras
Сергей Тонков
доверие
Коньково
марки на алкоголь
продукция местных производителей
Эквио
Pitta Mask
Яндекс.Дзен
Mars Petcare
открытие ресторана
Балашиха
социальная инициатива
доброшрифт
магазин у дома
Практика поставщика
Дмитрий Леонов
подарочные сертификаты
импортные производители
Олег Григорьев
Дмитрий Песков
Кремль
интерактивный помощник
плавленый сыр
«Кино Окко»
«Синема Парк»
«Формула Кино»
Ирина Платонова
Андрей Ушаков
концепт-стор
H&M HOME
Сергей Гончаров
спонтанные покупки
«Сима-ленд»
Александр Изосимов
уставной капитал
DIALOG
«O2O»
закрытие сделки
Рене Пикард
Денис Арсентьев
Операционный директор
PROMOSTYL
Zongshuge
FRUIT&GOOD
НАША ПЕКАРНЯ
PCHELOVE
SUPER
Анна Жданова
покупательский опыт
Genotek
Weekday
Urban tech
полезное питание
пожилые люди
Торстен Хубнер
социальная ответственность
доставка лекарств
«Все аптеки»
СберЗдоровье
ЗОЖ-продукты
речевой робот
Андрей Травников
магазин на диване
Новорижское шоссе
Estate Mall
Prognosis
Сергей Сбитнев
обучение персонала
Лариса Бодягина
оплата с помощью ладони
ANSALIGY
Тина Канделаки
утюги
прослушка
Российский топливный союз
РТС
топливо
рефинансирование
Скрепыши
оценка работодателей
Marathon Group
пищевая промышленность
Столплит
i-Media
Мария Гудкова
Надежда Романова
Ольга Сатановская
Cosmodrome Games
музыкальные инструменты
Роман Каплин
Александр Агаков
переобучение
ResearchMe
«Фуд Сити»
электрогрузовик
IDS Borjomi Russia
кулинарные изделия
контент-маркетинг
Sally Beauty
JetBlue
Ritz Carlton
MAPCO
DSW
Harry's
Б.Ю. Александров
продукты навынос
вторая волна
ТРЦ Щелковский
iPhone 12
дизайн-студия
Ольга Наумова
BSH Hausgeräte GmbH
посудомоечная машина
Алиса
рич-контент
Филипп Денисов
LANDOR & FITCH
Почта Армении
SberBox
видеошопинг
AERO Conference
Яндекс Go
магазин без кассиров
Герман Греф
Сбер
Моя цена
ООО «Ариадна-96»
NGENIX
Валерий Писарьков
Увелка
Пять Поваров
Проксима
Русский продукт
Подравка
Cambells
SN Maschinenbau
Анатолий Ширлин
Uncle Ben's
ТРК VEGAS Каширское шоссе
«Доброцен»
Олег Тиньков
Дания Ткачева
Артур Эльканов
крепкий алкоголь
Duracell
зарядное устройство
страхи
электротранспорт
Лариса Малькова
Кирилл Лавров
цифровая трансформация
AWG
Александр Хачиян
Tamaris
примерка
районные центры
Retail TECH WEB
ЮKassa
Кирилл Войцехович-Казанцев
i-Coffee
Анна Миланович
Максим Ликсутов
народный каршеринг
голосовые помощники
мониторы
условия труда
«РИГАМОЛЛ»
коммерческое предложение
Paper Planes
Илья Балахнин
Stake
Tokyo Otaku Mode
REI
Canon
КАРО
adidas TERREX
Oscar De La Renta
ЕГРИП
суперстор
Руслан Исмаилов
Veeam
Владимир Клявин
OMD
Jules
Дебби Уайнштайн
Авито.Недвижимость
здоровье
Илья Зинченко
снеки
Калмыкия
Утконос ОНЛАЙН
Сергей Оленцов
Вероника Грибова
право
RetailTrusts
Евгения Булавицкая
Poison Drop
Винзавод
Kangol
интерьер
M•A•C
Яндекс.Облако
Helptomama
retailrocket
Центральный рынок
материальное положение
спа
гостиница
digital health
Захар Вальков
УК MLP
Глеб Белавин
Константин Фомиченко
бизнес-анализ
JD Sports
Canadian Tire
Андрей Капранов
Brookfield Property Partners LP
Simon Property Group Inc.
VERME
NYX
G2
ПСБ
Иннокентий Воловик
упоминание в СМИ
Under Armor
на_полке
Биокард Логистикс
Apple AirPods
ДамПродам
Нестле Пурина ПетКер
Nespresso
Илья Микин
RUBAN
Алиса Рубан
Юлия Рубан
Ольга Демидова
eSolutions
Инна Магдалюк
фирменный магазин
МобиТел
TECNO Mobile
«Нэфис Косметикс»
AOS
товары местных производителей
виноград
российские дизайнеры
жизненно необходимые лекарства
неурожай
подсолнечное масло
Push4Site
amoCRM
МойСклад
Jivo
Nethouse
Денис Имшенецкий
RPA
Softline
Станислав Маслов
Даниил Берг
StyleKorean
беспошлинная торговля
партнерская программа
бородинский хлеб
Калининградская область
качество жизни
Euromonitor International
GigAnt
Денис Решанов
Рената Юраш
Анастасия Ивлеева
Tide
Марина Кравец
амбассадор
покупательная способность
фуд-трак
День знаний
массовый персонал
овсянка
ликерное вино
LunchBox
Madyar
Антей
Spider Group
Сергей Мелихов
LEDVANCE
Екатерина Журавлева
Familia
овсяные хлопья
Сбербанк ID
Сберавто
бизнес-модель
«Деловые Линии»
Linde
Катрен
Нижфарм
Акрихин
Бипласт
Борис Ашмарин
Пиком
парк
Герман Тинга
Владимир Сорокин
IT и финтех стартап
PIM Solutions
Goood’s House
CloudPayments
фуд-корт
голосовой помощник
Книга жалоб
единая идентификация
Егор Клименко
управление запасами
подработка
МФЦ
оплата картой
Марвел-Логистика
Мир кубиков
Михаил Захаров
Morgan & Morgan
Trello
Ztylus
JPMorgan Chase
WoolOvers
Impulse.guru
Илья Русаков
аутлет-деревня Zsar
Неделя Ритейла
автопарк
товары повседневного спроса
промокод
White Label Products
Владислав Губин
Игорь Бухаров
Сергей Капков
Максим Лучин
Макс Беляев
Олимпиада Знаменская
Андрей Фомин
Едадил
Ивановская область
налог на имущество
таргетинг
Google Analytics
Яндекс.Метрика
МТС Твой Бизнес
Дарья Ведерникова
аудиокниги
Wink
Сергей Анурьев
Pulanna
Maybelline
Lumene
Biotherm
Pupa
Max Factor
Schwarzkopf
Salvador Dali
Moschino
Paco Rabanne
Сhanel
Givenchy
Сергей Шнайдер
Владимир Некрасов
Макси Девелопмент
соки
Rich
Росинтер Ресторантс
предоплата
Перекрёсток Впрок
пандомат
Longines
БИФИТ Касса
Антон Толстокоров
поиск товаров
Сергей Саргсян
Elemento Systems
Персонал
суббренды
чек-лист
онлайн-образование
домашнее обучение
бары
навигация
12 STOREEZ
Akhmadullina Dreams
Евгений Колунов
Great Steve
PR Partner
Fountain Digital Labs
Облакотека
Кристина Стулова
Инна Анисимова
Светлана Драгаева
Максим Захаренко
Наталья Сторожева
Сингапур
Зоозавр
наливайка
Lindt
Олаф Кох
режим труда и отдыха
водитель
чипсы
Patrick Roger
госпошлина
МФК Green Park
Worki
баранина
TelePort
Альтервест
микроволновка
Snickers
растительный тунец
вегетарианские продукты
кадастровая оценка
shop-in-shop
корнер
авокадо
PUTIN TEAM
Brand Finance
Hollister
JanSport
Staples
санитайзеры
Momenta Pharmaceuticals
ECOM Expo’20
Юрий Левитас
закусочные
Максим Галкин
кассы самообслуживания
сеть кондитерских
Kuzina
D’S Damat
Go
халяльное меню
Lucky Snacky
свободные деньги
алкомаркеты
соусы
Knorr
АССА
Кодекс добросовестных практик
рецептурные лекарства
безрецептурные лекарства
ZenMarket
Purina
WeWork
власти
Philip Morris Prodacts С.А.
изделия из нагреваемого табака
KT&G
Facebook Pay
виртуальная примерка
садовый инвентарь
STIHL
Алые паруса
Домодедово
Портал поставщиков
СДТ
Макси Тойз
Продаем
Работа.ру
Diesel
гибкий офис
Деловая Россия
бизнес-посол
фуд-холл
Eat Market
товары для животных
допэмиссия
носки
экосистема
Vezubr
Экомаркет
Weilandt Elektronik
интеллектуальная собственность
кадры
пылесос
ПФК ЦСКА
калории
меню
Route-to-market
НОВЭКС
ЕНВД
Архангельская область
десерт
торты на заказ
Сeconomy
ресторан
Тамбовская область
CLUB 500
задолженность
коворкинг
ЦИАН
Группа М.Видео-Эльдорадо
Markswebb
мобильный банк
пенсия
Logsis
PLK
Tim Hortons
Restaurant Brands International
Restaurant Brands
импортные вина
BUD
BUD Light Non Alcoholic
Коптевский рынок
Северный рынок
сосиски
Магнит Сити
мини-маркет
открытие кафе
Paulig
школьная форма
Likee
легкий возврат
стриминг
виноградник
Достаевский
Mermaid+Me
Hello Body
Invincible Brands
картонная упаковка
бумажная упаковка
обновление
БАТ Россия
ветеринарная сертификация
пополнение
фин-тех
PimPay
фиксированные цены
Латинская Америка
дачные товары
Неделя Российского Ритейла
наличные деньги
канцелярия
школьные товары
Надежда Бабкина
Тимати
лимитированная коллекция
Lays
маршруты
Яндекс.Маршрутизация
Яндекс.Навигатор
международные переводы
Роскосмос
Махеевъ
Эссен Продакшн АГ
Михаил Галустян
Yum! Brands
крупногабаритные грузы
бахчевые культуры
дыня
Максим Левченко
путеводитель
Research.me
Агроном сад
прогнозирование
WeChat
Tencent
канцелярский набор школьника
производители
MyBook
Global Blue
пластик
Углече Поле
группа Little Big
Мур-мяу
Слово и дело
Байкал-Сервис ТК
ProStore by Lubivaya
необычный продукт
арбуз
Pfizer
Грег Абовский
Аркадий Волож
беспроводные наушники
Zewa
МСБ
Leeds
дочернее предприятие
автосалон
Анатолий Голомолзин
Международный розыск
Юрий Белойван
Корчма Тарас Бульба
1С-Битрикс
Milka
Ritter Sport
климатическая техника
Ночлежка
Vsemayki
Otto Group Russia
спам
Мурманская область
Евророс
потребительская уверенность
EGLO
винодельческие предприятия
EFFIE AWARDS RUSSIA
переработка
бутылки
тара
День работников торговли
День российской торговли
TikTok
Ozon.Card
социальные сети
гейминг
фотоотзывы
винотека
продажи
винный напиток
sms рассылка
контракт
кальян
Госдума
Новороссийск
ТРК Черноморский
алкоголизм
SPO
Beyond Meat
растительное мясо
минимальная цена
коньяк
махровые полотенца
фирменный стиль
хоккейный клуб «СИБИРЬ»
non-food
Fuel for Growth
фуд-тех
G’n’K
оформление витрин
Excel
выплаты
премирование
ТЦ Матрёшка
Яндекс.Директ
сезонность
Mars Food
корм для кошек
работа
Ян Дюннинг
онлайн-объявление
новая концепция
фирма-однодневка
подрядчики
диджитализация
роботизация
Авилон
Edisoft
виртуальные туры
Hermes Russia
Аркадий Новиков
Novikov Group
Святой источник
онлайн-заказ
Restart Vasilchuk Brothers
Чайхона №1
DiDi taxi
Борис Винкельманн
тепловая карта
компьютерное зрение
SimpleWine
Кофемания
Mediascope
Ксения Рясова
Буше
Сергей Емельченков
Skill Cup
Suunto
Wilson
Salomon
Amer Sports Russia
WWF
Xiao Long Group
Longchamp
Ecomarket.ru
Север-Метрополь
Две Палочки
Андрей Кривенко
Ольга Троценко
Почта Банк
ассоциации
Поисковые системы
InfoWatch
Эконива
Нефтехимкомплект
1С
Heathrow Airport
BP Global
Comarch
ждун
Денис Гуров
Eats
радуга
ЛГБТ
Nordstrom
Baskin Robbins
Marriott
The North Face
Casper
Splat
House of Lashes
Мосгортранс
качество обслуживания
Адыгейский сыр
Адыгея
FM Logistic
грузы
МТС Касса
регистрация
Делимобиль
кафе Prime
докризисный уровень
деловая активность
инсталляция
курьер
памятник
онлайн-витрина
Дмитрий Коробицын
Поставщик счастья
интим-товары
сеть пиццерий
пицца
Wendy's
Еаптека
StopHateForProfit
Анастасия Татулова
JTI Россия
Оптима
электронный документооборот
Synerdocs
дистрибьюторский центр
Japan Tobacco International
Juul
собственник
занятость
Пив&Ко
HEADO
St.Friday Socks
Мумий Тролль
Robokassa
Yummy United
премиальные бренды
&Other Stories
ментор
СКБ Контур
Home Market
ФРиО
беспилотные автомобили
DSM Group
паспорт
вакантность
подростки
деловая репутация
разрешение на торговлю
Ксения Собчак
Olympus
ТРЦ ГОРОД Косино
мировая торговля
фудкорт
логистическая инфраструктура
бизнес-идея
tentree
CVS
FIGS
Creators Club
товары для ухода за собой
возобновление работы
Sonia Rykiel
товары для отдыха
штаб-квартира
компания "МАЙ"
CURTIS
компетенции
черешня
рекомендации
товары для женщин
Libresse
обратная связь
Outlet Village Пулково
электронный чек
отказ от чеков
ГК «Руст»
логотип
расизм
рассрочка
dark kitchen
Click & Collect
NR LIVE
КАНТ
Эмма Уотсон
Эссен
суперприложение
рестораторы
подкаст
отделочные материалы
РКИФ
ККТ
R-Keeper
CSI
контрольно-кассовая техника
Елена Цысарь
киберсталкинг
WhatsApp
расписание
мерч
дискриминация
The Body Shop
Росстандарт
Петропавловск-Камчатский
бирбокс
масштабирование
Tork
Дмитрий Чупаха
Butik.ru
Generix Group Vostok
JOYBUY
социальная реклама
продуктоматы
логистический комплекс
Outlet Village Белая Дача
видеоконсультации
Ангстрем
гастропространство
Депо
рециркуляторы
DostavkaGuru
дезинфекция
средства дезинфекции
Комус
МаксиПРО
инструменты для ремонта
Brunello Cucinelli
The Outlet Moscow
цифровые товары
Давид Борзилов
покупка компании
Inditex Group
ANCOR
фармацевтический рынок
талисман
ресторан будущего
обслуживание
чат-бот
Global Talents Digital
обучающие курсы
GeekBrains
День России
режим работы
Дом моды
стилист
консультация
завод «СИБВЕЛЗ»
цифровой офис
FactorPlat
оборотный капитал
Торговый дом «Вимос»
факторинг
ХимРар
AB InBev
data science
SkillFactory
ФрутоНяня
Рыбалка и охота
сервелат
новинка
Rambler Group
Migros
Мартин Хубманн
Simon Property Group
отпуск
отдых
потребительское настроение
пакеты-майки
трансформация
CEO
Synergy Executive Forum
товары по уходу за кожей
Essity
TENA
дискаунтеры
Батон
автотовары
Александр Торбахов
Наблюдательный совет
Аэрофлот
защита бизнеса
риски
Domino’s Pizza
ФифаДерзай
Фрекен БОК
BlaBlaCar
JYSK
директор по продажам
hh.ru
MAPIC Russia
food retail
фудмолл "Депо"
Minecraft
bonprix
Авито.Работа
очередь
Ангара
диван
одежда для работы
мужская одежда
регулярные рейсы
цепи поставок
ТЦ «Океания»
Zalando
Зимняя вишня
потребительская активность
полуфабрикаты
туалетная вода
духи
Понтус Эрнтелл
оптовая торговля
открытие счета
пункты выдачи
Exponea
товарные остатки
Алексей Баулин
рынок доставки
препараты от ОРВИ
сокращение бонусов
Райффайзенбанк
облигации
эмиссия
пополнение карт
снятие наличных на кассах магазинов
маски
безналичные платежи
товары для спорта
декор
женская одежда
Alena Akhmadullina
сметана
дистанционная торговля
цифровые коды
товары для активного отдыха
медицинская сфера
Торговое оборудование
новое оборудование
видеоаналитика
почтовые отделения
Ярмарка Мастеров
Артем Соколов
китайские магазины
онлайн-шопинг
Технопарк
KazanMall
центр экспертизы
Ingka Centres
бакалея
Татьяна Бакальчук
Сахалинская область
физические лица
оптовые закупки
гастрономы
результаты продаж
найм сотрудников
онлайн-собеседования
Росреестр
электронное меню
новые правила работы
Rate&Goods
Командор
сокращение точек продаж
Система быстрых платежей
СБП
Анатолий Шутка
5Post
Александр Гольцов
Всеинструменты.ру
террор
фейк
оборудование
финансирование
катастрофа
Ситимобил
социальное дистанцирование
сервис объявлений
карта «Тройка»
брелоки «Тройка»
кулинарные предпочтения
Якитория
наказание
состав продуктов
Михаил Васинкевич
товары по подписке
Whirlpool
PINKRABBIT
«Розовый кролик»
курица
мясные продукты
чаевые
Cainiao Network
AliExpress Россия
Цайняо
антикризисная поддержка
Zoom
рекрутинг
Госуслуги
товары для сна
игровые консоли
товары для ремонта
торговая инфраструктура
ТЕХНОНИКОЛЬ
оплата смартфоном
бесконтактная оплата
Сберлогистика
день рождения сети
магазин без продавцов
Group-IB
фишинговые схемы
роллы
японская кухня
Тануки
тестирование
антисептик
товары первой необходимости
отсрочка по налогам
ВсемРабота
приготовление блюд
бесконтактная доставка
предприятие
цепочка поставок
индекс деловой активности
ТЦ «Птичий рынок» в Казани
Михаил Мишустин
правила работы магазинов
магазины стройматериалов
Honor
доля рынка
суд по интеллектуальным правам
конфеты
Rafffaello
Саид Гуцериев
Михаил Гуцериев
арендодатели
продукты с большим сроком годности
эффективность
покупки в кредит
потребительское кредитование
Красный Яр
Батончик
ГК «Красный Яр»
кафе в жилом доме
велосипеды
морепродукты
мышьяк
креветки
Printemps
Galeries Lafayette
Честный ЗНАК
МКБ
Такском
Беру
Мега Парнас
Мега Дыбенко
RITA
пострадавшая отрасль
онлайн-игры
онлайн-траты
рынок труда
самый богатый человек мира
проверка
масочный режим
мобильное приложение
ТиНАО
Мосгосстройнадзор
онлайн-трансляция
групповые видеозвонки
распознавание лица
Москомстройинвест
публичные слушания
МСП
Даниил Егоров
грант
Андерсон
Яндекс.Маркет Аналитика
проигрыватели
виниловые пластинки
виниловые диски
Республика
непродовольственный ритейл
Росчайкофе
продавцы
Дача, сад, огород
Brandquad
Colliers International
роялти
еда на заказ
s.Oliver Shoes
Джери Калмис
Imperial Tobacco
табачные компании
готовые блюда
народные промыслы
Иннополис
управление
покупательское поведение
фулфилмент центр
Дагмара Иванова
директор по маркетингу
отмена маркировки
РАТЭК
фототехника
Выручай-карта
даркстор
дешевые товары
Accenture
бизнес-процессы
foodtech
главный исполнительный директор
SberFood
Гюванч Донмез
Словакия
новый рынок
продукты питания
Группа «Коноплекс»
продукция из конопли
Gett Delivery
быстрая доставка
Westfalika
издательство «Феникс»
устойчивое развитие
меры поддержки
обращение
отказ от покупки
Рамзан Кадыров
Чечня
машинка для стрижки волос
Российский совет торговых центров
товары для красоты
летние веранды
снятие ограничений
потребление
холодильник
товары для дома
креатив
Иван Ургант
Юрий Дудь
инфлюенсер
слабоалкогольные напитки
Эльдорадости
трудоустройство
лимит по покупкам
Леонид Довладбегян
Perekrestok.ru
СберМаркет
Яндекс Лавка
Самокат
корпоративные закупки
бонусы
юридическое лицо
Пол Роговски
Флориан Янсен
российская символика
Андрей Кленин
режим самоограничений
AB InBev Efes
менеджмент качества
перчатки
Индира Шафикова
Антон Реутов
Smart Estate Moscow
Михаил Петров
консьерж-сервис
Григорий Кунис
iGooods
потребительское поведение
iPhone SE
reStore
Игорь Шехтерман
VEON
товары для туризма
Data Matrix
автомобильные шины
ЦРПТ
Райт
трудовое законодательство
локальные бренды
восстановление рынка
увольнение
дополнительный заработок
носимые устройства
форс-мажор
ЦСКА
Сгущенка
Бургер Кинг
Доля в бизнесе
Владимир Чирахов
Медицинские маски
Библиотека ароматов
посуда
e-grocery
Последняя миля
Кухня на районе
Dark Store
домашние животные
Текстиль
Квартиротека
Экологичные товары
Уборка
искусственное мясо
Садоводство
фрикадельки ИКЕА
юбилей
системообразующие предприятия
пандемия
самоизоляция
Блохэй
J.C.Penney
заправки
Газпромнефть
карантин
коронавирус
COVID-19
удаленная работа
2ГИС
Google Maps
Яндекс Карты
Kidsby
Tik Tok
блогеры
Fashion Tech Day
trade-in
Минтруд
IML
Яндекс Еда
Красное&Белое
гастромаркеты
Ленторг
ОБИ
Усачевский рынок
Joom
нейромаркетинг
криминал
COS
Бетховен
Fujifilm
Интерпол
Ariston
Удмуртия
Индонезия
Максим
e-bay
Меркурий
Tous
Vertu
Viber
блокировка
самозанятые
цифровизация
Глобал Молл
MAPIC2018
vivo
Dino Zoo
кастомизация
Союз пивоваров России
контрабанда
система управления задачами
Вилон
Красный крест
Flormar
Choupette
Calzedonia
ShopAndMall
Reserved
OREO
ICO
Liu Jo
Dodo Pizza
выборы
Swarovski
tervolina
лукойл
Bayer
La Perla
Союзмультфильм
антиквариат
ТПП
AXE
онлайн vs. офлайн
Absolut
ИТ-директор
Première Vision
Настюша
ПОЗИТРОНИКА
leform
Белая дача
телемедицина
Chupa Chups
Under Armour
утраты
СДЭК
Такси
MODI
Папа Джонс
Магнолия
La Redoute
OFFPRICE
Дымов
каршеринг
geox
Твой Дом
zasport
я
минеральная вода
ADG Group
MAPIC 2017
МЦК
Герман Стерлигов
iHerb
Диверсус Групп
флагманский магазин
Моя улица
Зарядье
Торговый дом
Стильпарк
goods.ru
Альфа-Банк
Амвэй
Contact Center in Retail
Fresh Russian Communications Conference
SOKOLOV
визуальный мерчандайзинг
VM GURU
Борис Агатов
Премия «Финансовый Олимп»
RIW
Брусника
Moscow Licensing Summit
Товары для взрослых
Алмаз-Холдинг
TouchBank
Russian Blockhain Week
Дэйв Логан
Марк Гоулстон
Совесть
Мосшуз
IGCONF
Пресс-служба
YouDo
итоги конференции
Реновация Москвы
ЭльдоGame
CNEWS Forum
Медиалидер
Платформа ОФД
InterCHARM
Digital Signage
Cozy Home
Электронная торговля
Смоленский пассаж
Robinzon Premier
Меджик Библиотека
ТРК "Красный Кит"
SOCIAL MEDIA FEST
Exalis Russia
Première Vision Paris
РИФ
Navicon
вредные советы
швейное производство
чековые принтеры
Citizen
островная торговля
Минсвязи
54-ФЗ
корейская косметика
Too Cool For Scholl
Л'Этуаль
майнинг
умный дом
Югра Молл
Watcom
кинотеатр
Охта Молл
интернет-реклама
СРМ
субаренда
Мегаленд
CNews
Охапка
VeeRoute
ТЦ Колорит
Vegas
Cushman & Wakefield
Рекламная кампания
Банк Хоум Кредит
Candy
Digift
Quiksilver
Йармарка
ПЭК
Redis Business Class
Банк Открытие
Проектор
Российская Неделя Продаж
UPS
Gorenje
Руспродсоюз
Айсберри
Stack Group
Trade Marketing Forum
Russian Enterprise Content Summit
DMC
Synergy Global Forum
Московский Кредитный Банк
ТРК Родео Драйв
Дисплеи
Fujitsu World Tour
кухни Мария
дальневосточный гектар
Lady Collection
КРОК
беспроводные колонки
JBL
М.Видео
Кошелёк
РАФИ
ФСК Лидер
Drichmann
контекстная реклама
Олег Брагинский
Arket
ModaHSE
Денис Яхно
ликвидация продуктов
АККОНД
Кредиты и рассрочки
электромобили
Семь пятниц
Массандра
зонты
рост импорта
Birkin
кэшбек
MIO
семинар
SEO
Онлайн-конференция
МаксиПост
РСТЦ
ТК «ГудОк
ущерб
Whole Foods
Мегаполис
сим-карты
МФО
Налоговое планирование
UBANK
Халва
Совкомбанк
МФУ
Xerox
Экскурсия
автопроизводители
FIFA
оптовые центры
тренинг
Дмитрий Ткаченко
подписная кампания
призы
розыгрыш
голосование
Retailer of the Year
ВкусLab
магазин приложений
EvoStore
Эвотор
Tutti Frutti
вирус
Тимур Асланов
Людмила Семушина
Антикризисный PR
Retail Business Russia&EAEU
RBR
Holland & Barrett
Даблби
Novardis
наушники
Ростех
новый сервис
Эстония
ягоды
сервис доставки еды
Евродон
бракованная продукция
Дочки-сыночки
Slack
соцсети
открытие рынка
Звездный
пельмени
Verizon
M&M’s
Ромир
Rendez-Vous
ТЦ Горбушкин двор
смена владельца
Гифтоман
Black Star
Северная Осетия
клиентский сервис
Клининг
продуктовый набор
помощь бизнесу
LADOGA
мед
жилые дома
центениалы
Алекна
Lidl
Юла
приставы
gett
онлайн-платежи
зоотовары
Авто.ру
Даниловский рынок
Ginza Project
Braccialini
Johnson & Johnson
Sergio Rossi
торговые наценки
Ювелирторг
ZakaZaka
Mitsui
Р-Фарм
«Любимый край»
алкоэнергетики
Глобэкс
Ригла
Kiko Milano
Максим Ноготков
Виктория Бекхэм
Золотое яблоко
текучка
Laduree
пенсионеры
Тамагочи
российская кухня
реконструкция
«Живика»
опиумный мак
killfish
Пятигорск
Дагестан
Kraft Heinz
Александр Мамут
Фулфилмент
Gillette
SCA
biglion
МРОТ
Askona
Мортадель
персонализация
ВкусВилл
Приморье
VR
ТРЦ Саларис
CBRE
спиртосодержащие жидкости
расширение ассортимента
Ginza Holding
Gamestop
Cstore
продуктовая корзина
ТРЦ Авиапарк
закупочные цены
постные продукты
Геннадий Тимченко
сокращение сети
спиртосодержащие лекарства
локализация производства
самые дорогие города мира
Brioni
скоропортящиеся продукты
трафик
самообслуживание
клиентский опыт
Forma
средний чек
рынок обуви
Чиббис
Neiman Marcus
Hudson's Bay
домены
Black Star Burger
ананасы
стандарты
консалтинг
Артемий Лебедев
Ivanka Trump
Meizu
Amway
ПЭТ-упаковки
шерсть
Лукошко
Полушка
шпроты
Galaxy Note 7
Philips
Теремок
Лабиринт
Kate Spade
вейпы
J7
собственное производство
грибы
Стас Михайлов
LFL
Иванка Трамп
пуховики
малые сети
Леди Гага
рис
каширский двор
milavitsa
Wet Seal
Московский ювелирный завод
MoneyGram
вода
Яшма
отзыв продукции
тарифы
Свинка Пеппа
правообладатель
Pierre Cardin
потребительская корзина
обновление концепции
Moscow Duty Free
международные бренды
спонсоры
Supreme
Tima Code
Айсель Трудел
Пенсионный фонд
срыв сделки
сыроварня
программы лояльности
Верховный суд России
совместное предприятие
Сафмар
фальсификация
ресторанный бизнес
Минюст
Эди Слиман
Coty
мясо
Boxberry
Подружка
страховые взносы
Генпрокуратура
студенты
мандарины
Дальний Восток
мёд
рив гош
займы
Уралсиб
коллапс
постаматы
Android Pay
закупки
Звездные воины
цифровой контент
робототехника
Тимур Бекмамбетов
Боярышник
правоохранительные органы
Ирландия
расследование
CardsMobile
Блэк Фрайдэй
Pizza Hut
договоры
Kenzo
религия
устрицы
мидии
Silver&Silver
Philipp Plein
аудит
Ирина Яровая
растительное масло
соглашение
коллаборация
United Colors of Benetton
платформа
личный опыт
Битрикс24
Союзплодимпорт
shopping index
кредиторы
Norman Asset Management
Новый Арбат
Модный континент
легкая промышленность
прилипалы
Electrolux
RitterSport
SC Johnson
Mondelez
Валентин Юдашкин
эксперимент
подарочные карты
совет директоров
La Senza
Zvooq
низкий ценовой сегмент
Алексей Улюкаев
взятка
Mascotte
День Холостяка
помидоры
Undiz
Джинсовая симфония
торговый центр
Владивостокский ГУМ
реструктуризация
Рустам Тарико
Ralph Lauren Polo
футбол
Дональд Трамп
Richemont Group
аграрный бизнес
Абрамович
«Эркафарм»
CTM
Souq.com
облачные технологии
«Вимм-Билль-Данн»
Papa John's
агрохолдинг
Кунцевский рынок
LTE
GoTech
А1
кобрендинг
астрология
конфискация
тайный покупатель
Coach
купоны
лизинг
общепит
PR
кибербезопасность
хакатон
НАДТ
Узбекистан
серый рынок
Pepe Jeans
Movistar
Mandarina Duck
РЭЦ
Durex
Cofix
продовольственные запасы
Gremm Group
фуд-маркет
ПЛАС-Форум
Smurfit Kappa
Veta
электронные сигареты
работодатель
торговая площадка
реконцепция
Петровский пассаж
ателье
«Зубровка»
«Адамант»
Игорь Чайка
Dunkin' Donuts
New Retail
West Elm
бутик-отель
залог
Каравай
оплата
биометрия
Полный ритейл
Сирия
геймификация
Uber
Садовое кольцо
благотворительные фонды
Claire`s
Академия ритейла
Яндекс Такси
Honest
Barbie
краудфандинг
продажа
пресса
Поволжье
Wrangler
Hunkemoller
Hunkemöller
Wrigley
цитрусовые
лимоны
топ-менеджмент
краудсорсинг
Alexander Wang
Милан
CRM Solutions
лайфстайл
доставка
полиция
«Баскин Роббинс»
платежный сервис
фабрика
споры
онлайн-кинотеатр
квесты
подделки
онлайн-кассы
BHS
родители
школа
буркини
Signet Jewelers
Одесса
ВТБ24
Дефиле
Delivery Club
вебинар
пальмовое масло
Гвинет Пэлтроу
lifestile
почта
TAG Heuer
дополненная реальность
подписка
Messenger
рекламодатели
Всемирный торговый центр
теракт
бизнес-завтрак
третейский суд
техрегламент
Offrice
ЦКАД
прокат
фриланс
клиент
поиск работы
мобильные платежи
история успеха
Эмин Агаларов
Максим Фадеев
Росалкогольрегулирование
SsangYong
гольф
К-руока
пекарни
сказки
маркировка
АЗС
омниканальность
сантехника
Бразилия
нижнее белье
приложение
«Дикая Орхидея»
стресс
Mamas&Papas
арест счетов
LeEco
Байкал
Pokemon Go
административное дело
универмаги
Минтранс
новая коллекция
собаки
Trussardi
колбаса
Kinder
ЧМ -2018
шампанское
Jouvence Eternelle
аэропорт
карта «Мир»
ремонт
мессенджеры
Brexit
Минобрнауки
новый формат
образование
Следственный комитет
предзаказ
Урал
здоровое питание
ОРЦ
производитель
КоАП
кадровая политика
протест
Фонд Сколково
бенефициарный владелец
Иркутская область
Lion of Porches
Интернет вещей
промоакции
Startup Village
конференция
пивоварни
Опора России
House
шопоголик
Александр Шпетный
Faberlic
фрукты
идея
кофейни
вендинг
Carprice
мерчендайзинг
коммуникации
этикет
Оскар Хартманн
операционная система
Бельгия
искусственный интеллект
тайм-менеджмент
Верховный суд США
ТРЦ Columbus
программное обеспечение
киберпреступники
исследование
банкомат
programmatic
рrogrammatic
Zappos
онлайн-аутлет
продвижение
Стинг
манипуляции
ЦУМ Воронеж
электронные ценники
акселератор
колонка
блокчейн
Airbnb
переход на новые ККТ
венчурный фонд
Алло
Kiki Milano
PickPoint
Terranova
LPP
ДЗЗ
Фасоль
модные показы
меховые изделия
новая бизнес-реальность
развитие бизнеса
продуктовый подход
sales
product development
дрогери
Zeppelin
К-раута
Kindle
Kiabi
Военторг
масс-маркет
дизайнеры
спирт
Tom Tailor
Росконтроль
Monsoon Accessorize
Podium Market
Samsonite
оптимизация конверсии
целевая аудитория
Всеволод Страх
снос
Estee Lauder
TARDINI
Оптоклуб РЯДЫ
Додо Пицца
Mars
ТЦ Пирамида
digital
Motivi
Stella McCartney
Tele2
Aktivo
Oysho
Koton
Celine
самострои
Fott
Улыбка радуги
онлайн-курсы
МОЛКОМ
Converse
Reiss
Lancome
ERES
Kidzania
Эвалар
Борис Титов
TopDelivery
Giorgio Armani
возврат товаров
миллениалы
смена руководства
ФНС
Яндекс Касса
Мифы
Сбарро
Hello Kitty
система видеонаблюдения
безработица
планирование
Мозговой штурм
Ted Baker
Farfetch
Toshiba
Русагро
Планета суши
Jonathan Saunders
Krizia
Глобуc
Тельман Исмаилов
Waikiki
Marni
Платон
Черная пятница
аромамаркетинг
plus-size
Tom Ford
печенье
Алена Владимирская
Posti
Холодильник.ру
аудиомаркетинг
Moncler
арест имущества
The Furnish
Gentiluomo scarpe
Мезоджи
судебные органы
11.11
Omega
Огни столицы
Брайан Трейси
торги
Balmain
Asda
виртуальная реальность
Overstock
офлайн-формат
дроны
нормативы
мыло
Баба Валя
Дмитрий Лисицкий
Allbiz
Exist.ru
KORNERS
Джефф Безос
долги
Swatch
кражи
аутлеты
Nickelodeon
Columbus
American Apparel
Ralph Lauren
текстильщики
MODIS
шоу-рум
Верный
Oodji
маркетплейсы
Macy's
Instacart
ретаргетинг
Сетка
Saint Laurent
управление проектами
нетворкинг
репутация
fast fashion
Zarina
Reebok
Джейн Биркин
дайджест
БТиЭ-ритейлеры
ASOS
траблшутер
Christian Louboutin
LINGERIE SHOW-FORUM
эффект губной помады
Губка Боб
дресс-код
стиль
дисконтные карты
освещение в ритейле
рост рынка
Ицхак Адизес
Rookie
Céline
Marc Jacobs
Alexander McQueen
Concept Group
Mary Kay
Nasty Gal
ТРК "Галерея"
Здоровый малыш
кейсы
Триколор ТВ
санкционные продукты
Смартори
свое дело
категорийный менеджмент
SIM-карты
Polyvore
Polvorey
Polvore
Владимир Потанин
Мамагазин
Diva
карьера
Яндекс Доставка
учет товаров
инвестиции
служба поддержки
Молоток.ру
интернет-аукционы
befree
рынок нижнего белья
Глобус Гурмэ
American Eagle Outfitters
Петрович
Vero Moda
газировка
лимонад
собеседование
речь
команда
Эдуард Остроброд
стенография
слепая печать
скорочтение
Красная Москва
запах
морской
миллионер
на заказ
Donna Karan
философ
ЕГАИС
тренер
голос
мороженое
центр исполнения заказов
примерочная
панда
чехол
аксессуар
клубника
свадьба
ГИС-система
Sears
мерчандайзинг
какао
швейцарские часы
НЭП
Википедия
Я Любимый
Белый ветер Цифровой
LinkedIn
сотрудник
СПИК
фронт-маржа
ретробонусы
Недели Российского Ритейла
коллеги
юбка
НБА
Brandbuilding
производство соков
iBeacon
indoor
Алексей Кузьмин
Ушастый нянь
ИП
виски
иконки
Virgin
Ричард Бренсон
ЦентрОбувь
Диета-18
сон
торговый сбор
Донбасс
медиа
Грозный
Нэфис
нематериальный
levi's
KFC
эмоции
Латвия
ошибка
гаджеты
школьник
советский
правительство Москвы
личная эффективность
выходные
переписка
e-mail
совместное потребление
Бизнес Лифт
Олег Иванов
телефон
лень
Мировой
игра
Артек
Брусничка
Кузнецкий мост
будущее
магазины на колесах
весна
Aldi
ужасы
Аникс
понимание
общение
энергоэффективность
Максим Недякин
Токио
принцесса
успех
лидер
Каннский фестиваль
JD.com
зерно
Горбачев
очки
Dirk
Ассоциация предпринимателей-мусульман РФ
Перенос данных
менеджер
Pollichini
свастика
маркетинг момента
меланхолия
Калифорния
засуха
балетки
Страшный сон вегана
Владимир Жириновский
агентство
мотивация
Хамадей
СМИ
Nati
РИФ+КИБ
Дмитрий Костыгин
Richemont
Роскачество
теория поколений
Связной банк
комбинезон
POS-терминал
Michelin
Оренбург
E96
Ютинет
сбой в работе
CNDD
ИЛЬ ДЕ БОТЭ
Арконада
«Бристоль»
рынок
Schiaparelli
новый проект
лекарства
Александр Ткачев
консультант
секонд-хенд
Monki
аутсорсинг
зелёное строительство
лояльность
выпускной
платье
Mercedes-Benz Fashion Week Almaty
Севастополь
винил
Vegeta
pop-up
Mead Johnson
этический кодекс
универмаг "Москва"
Сулейман Керимов
Модный сезон
звезда
селебрити
Kari
упаковка
Олег Малис
документооборот
запрет на торговлю
Красная площадь
Hauber
текст
Питер Дундас
Roberto Cavalli
Pronovias
детская одежда
ввоз товаров
плагиат
Inkerman
Легенда Крыма
Philip Morris
табачный рынок
деним
джинсы
шопинг
кроссовки
официант
Николай Фоменко
Дека
писатель
Ассорти
БРИКС
Великая Отечественная война
Ржевка Групп
вакансии
B2B-Center
Henkel
ИдеаЛоджик
Furla
Zimmerli
тренажерный зал
Фитнес
Nina Ricci
сервис доставки товаров
AIZEL.ru
продуктовые магазины
DIY
черноморские устрицы
параллельный импорт
«Едим дома!»
РФПИ
Porta 9
обувь
Otto Group
товары для мам
молебны
МФК «Ханой-Москва»
март
Никита Михалков
Андрей Кончаловский
CallBackHunter
Zalora
Namshi
Jabong
Dafiti
Global Fashion Group
нестационарная торговля
TNT Express
FedEx
экспресс-доставка
ДЛТ
АгриВолга
Ол!Гуд
мигранты
мигратны
DeFacto
господдержка
Зона свободной торговли
Вьетнам
Ингушетия
лжеминеры
«Рот Фронт»
арахис
комиссия по импортозамещению
FashionUnited
теневой рынок
моющие средства
запрет на товарные поставки
книжный магазин
Tribuna
ЦДМ на Лубянке
Qiwi Post
Литрес
запрет на торговлю ночью
HEINEKEN
доставка готовой еды
НСПК
обыски
погашение долгов
Dash Button
бытовая химия
Caviar
PayMaster
Yoox
Mary Cay
Teleperfomance
Тинькофф Банк
Hamleys
Яндекс Маркет
сувениры
Киберри
безалкогольные напитки
Net-a-Porter
копирайтинг
Carlsberg Group
ГК «Ташир»
звонки о заминировании
телефонный терроризм
Obuv.com
ТВОЕ
шантаж
Kraft Foods
Heinz
слияние компаний
интернет-проекты
DuFry
клад
Промсвязьбанк
Образование
Rio Tinto Diamonds
De Beers
«АЛРОСА»
call-center
нелегальный бизнес
Цветной
Eva B. Bitzer
российский рынок белья
ООО Бенат
Dilmah
Unilever
ЦВЗ
Lowe's
Essence Development
страны
единые закупки
«Дрогери Союз»
вегетариантство
Versace
ангора
Фрау Техника
Westfalika Kids
WestfalikaHome
TradeEase
ветераны
СТМ
авторские права
отпускные цены
руководитель
монетизация
живой журнал
Chanel
Краснобор
мясо индейки
City Express
Westfalika.ru
ЛНР
ТЦ Сити-Молл
эвакуация
Subway
сайт
корпоративная культура
Rich Family
антибиотики
Fort Group
продажа брендов
вендинговые киоски
продажа торговой сети
Kesko
Албания
Орел
приостановка производства
автопробег
Roust
British American Tobacco
экономия
перестройка
Yamaha
ТЦ Адмирал
9 мая
спор
«Русское молоко»
города
детское питание
выступление
ценовой сговор
СТС Media
крупы
ВДНХ
космическая еда
фреш
Snapchat
Hines
ошибка в кассовой системе
S-Ryhmä
рост тарифов
дело
Google Shop
электронные книги
PocketBook
HANRO
Grand Defile Lingerie
CPM
Ростелеком
иномарки
АЛИДИ
соглашение о рыбном хозяйстве
Пичетт
соцтовары
оптовые цены
Crest
конверсия
девальвация нацвалюты
лари
продажа ТРЦ
необычный товар
инцидент
МОК
Dow Jones
Guinness
Tmall.com
Да!
соцакция
Швеция
ТД "Гулливер и Ко"
VIMN
УК «Еврокапитал»
бренды
ритейлер года
награда
Мария-Ра
деловой форум
b2b
сумки
Fendi
Prada
инвесторы
таможенные сборы
праздничный стол
собственная торговая марка
Венгрия
Интерторг
Луганск
Выставки и мероприятия
VendExpo
8 марта
Самарский регион
Тайвань
SnowGuard
программа развития
модернизация
концерн "Калашников"
докапитализация
C-store
Carlo Pazolini
слоган
мех
шуба
погода
Табрис
заводы
ломбарды
бытовая техника
FCG
Греция
Крымское подворье
Подмосковное подворье
зоомагазины
Читай-город
Буква
ДНР
Эльбрус Капитал
падение продаж
диета
похудение
Мексика
Павелецкий вокзал
Zenden
ТРК Европолис
Angry Birds
Diageo
фильм
Макфа
кондитерские изделия
шубы
Radius Group
распределительный центр
часы
оптимизация бизнеса
23 февраля
лосось
Фарерские острова
КНДР
B2C
антикризисные цены
EuroCIS
госаптеки
бизнес-форум
Online Retail Russia
самогонные аппараты
Проект "Кортеж"
трагедия
Lush
Мособлкнига
Domo
человек-легенда
митинг
Мосгордума
дешевые магазины
S-Tep
Decathlon
Русский алкоголь
Синегерия
Qiwi банк
детские сады
мультики
Lotte Group
следствие
силовые структуры
Хорошие новости
минимаркеты
Красный октябрь
Friday Market
День защитника Отечества
ГАЗ
Молдавия
жильё
квартиры
гендиректор
АВ маркет
переименовение
«Русская аквакультура»
Египет
провалы
ЧП
Kering
холодные звонки
Охрана
Groupon
онлайн-суды
авторские сборы
юрлица
PepsiCo
Ferrero
химикаты
доброта
мини-пекарни
автолавки
Пермский край
профицит
прокуратура
овощи
СК
рецепты
рынок электроники
дистрибуторы
Питерлэнд
Приднестровье
проектирование магазина
мужчины
Проект "Титан"
коммунизм
налоговые сборы
SPSR EXPRESS
закрытие проекта
«Виктория»
Lindex
Роструд
кухня
еда
Luxoft
Svoy.ru
персональные данные
РЦОД
Астерос
мясо енота
ажиотаж
Солнышко
госрегулирование
заключенные
ценообразование
рост вакантных мест
DPD
email-маркетинг
Reckitt Benckiser
выставка
промоиндустрия
IPSA
таможенные службы
Potevio
китайский рынок
PNN Group
Superdry
Opel
антикризисный план
микрокредитование
концепция магазина
Колос-Пром
предпраздничные дни
Цветы и растения
RUSPOLE BRANDS
Bonduelle
консервы
Qualcomm
импортеры
Canonical
Emilio Pucci
электронные платежи
фаблеты
кофемашины
кофейные капсулы
нормы поведения с клиентом
работа сотрудников
Skoda
павильоны
Концерн «Пять звезд»
бизнес-клуб
менеджмент
Moody's
Tmall Global
МЧС
пожар
содержание алкоголя в продукте
энергетические напитки
Carl's Junior
европейский рынок
беспилотники
Владимир
Финпотребсоюз
Эконика
НАСТ
продуктовые карточки
старт продаж
молоко
Бийск
Range Rover Sport
Стив Ли
Газпром
печатная продукция
онлайн-продажи
Knight Frank
Всемирный экономический форум
логистический оператор
Мессе Дюссельдорф
репортаж
отказ от работы
Spotify
сокращение затрат
неудачные переговоры
Овощные базы
Русьимпорт
Coca-Cola
MyTheresa
teXet
Алкотел
пенсии
пушнина
регулирование цен
исполнительный директор
синергия
офисы
DNS
ПАСЕ
Балтика
Audi
концепт-кар
iWatch
Enter Связной
Vis-a-vis
склады
P&G
витрины
Mattel
anywayanyday.com
запрещенные сайты
торговое законодательство
Fashion Galaxy
UGG Australia
HP
Dell
Tommy Hilfiger
Deloitte
история бренда
Rockport
Очаково
Calvin Klein
Zimmerli, Hanro и Derek Rose
Кети Хараидзе
мебель
видео
регулятор
Musicmetric
сокращение товара
криптовалюта
демонтаж
заморозка проектов
сибриды
Shazam
попкорн
Skrill
СПСР-Экспресс
SpaceX
Лаборатория Касперского
Eset
посылки
hybris
Forrester Research
Экспресс
обращения россиян
Shipito
Sollers
Турция
яйца
PNK Group
Крестьянское хозяйство А.П. Волкова
Кузбасс
радар
ZipDial
Кристалл
бриллианты
рабочий капитал
working capital
Химки
услуги
Items Area
Гроздь
Александр Ландо
BAON
кондитерская фабрика
нападения
премия
продавец
онлайн-аукционы
частные объявления
падение спроса
неон
Shenqi
тест
Tizen
Volvo
Лин Бин
Леруа Мерлен
BNS Group
Google Glass
Target
Венесуэла
Sberbank CIB
Фармакопейка
Mi Note Pro
Mi Note
Project Ara
кассир
прекращение продаж
женщины
Box2Box
Торгсин
Kikstarter
Ямал
Honda Pilot
Quanta Computer
Махачкала
First Development
ИжАвто
Nissan Tiida
Ericsson
Galaxy J1
Charlie Hebdo
Hervé Léger
iCloud
msi
Рынок материнских плат
ECS
О’КЕЙ
Киров
Квадрат
One 97 Communications
газеты и журналы
Минкомсвязи
универсам «Фрунзенский»
PlayStation 4
Ануш Гаспарян
Денис Мантуров
Таиланд
Citigroup
ОНФ
tax free
Черкизово
Кофе Хауз
Valve
Steam
МРЦ
тинэйджер
шпионаж
дефолт
Все для фанатов: как зарабатывают на продаже сопутствующей продукции телесериалов
Музыка
электронная почта
Стелла МакКартни
CES 2015
Nokia 215
Rolls-Royce
электронная коммерция
Suzuki
Ford
робот
ТРЦ Арена
Анна Мирочиненко
сахар
Great Wall
Uz-Daewoo
Автостат
Эксперт НСК
Datsun
Тихон Смыков
Молния
ВВП
Immofinanz
«Золотой Вавилон»
подарки
FactCloud
Galaxy Alpha
Samsung Galaxy A5
Amazon Prime
Nissan Qashqai
Серпухов
новогодний стол
Георгий Оксенойт
Glassdoor
John Lewis
Илья Шестаков
Росрыболовство
черная икра
Sanoma
журналы
лидеры продаж
телевизоры
Еврокомиссия
Зеленый перекресток
импортные продукты
хакеры
Sharp
история торговли
Polaroid
Hyundai
Kodak
Парк Горького
Фанагория
Индия
Bulgari
Максим Макин
Kia Rio
салоны красоты
девелоперы
платные парковки
Meine Liebe
Thomas Münz
Kaiser
Русское море
красная икра
молочная продукция
YotaPhone 3
Армия России
Дмитрий Булгаков
Военторг-Пятерочка
Владимир Русанов
Антон Силуанов
Андрей Белоусов
Standard & Poor’s
Apple Pay
ТРК Колумбус
торговые операторы
Анжела Сю
ставки
Газпромбанк
креативный директор
Магазин магазинов
Tengelmann Group
РЖС
компания Datsun
зарплата
Денис Кутников
Дэвид Чанг
Asus
Владислав Мартынов
Майкл Фроман
Бу Андерсон
Банк Траст
Mango Megastore
HTC
игровая индустрия
Михаил Бурмистров
закрытие магазина
Авито Авто
Томаш Вроблевски
Watsons
Mercedes
Павел Симонов
UCWeb
дилеры
Kia
театры
воровство
big data
цифровые технологии
мораторий
MEGATOP
клонирование
риелтор
риелтер
Стивен Спилберг
Юрий Никулин
Бред Питт
медицинские товары
Надежда Заречная
МаксиМед
НАЭСП
App Store
Renault
Mazda
Mitsubishi
Федор Гавриченко
рынок развлечений
фуд-ритейл
сокращение персонала
Юлия Сахарова
Илья Рябой
Пабло Исла
Top Shop
Ян Хеере
Дарья Ядерная
Денис Богатырев
Алексей Волин
Александр Оськин
Алексей Филатов
парфюмерия и косметика
Уржумский продукт
Вятич
Вятский квас
у.е.
ценники
остановка продукции
Simple
Сады Придонья
Land Rover
ФРИИ
Xbox One
PS4
Дания
Барак Обама
цифровой маркетинг
йогурт
кефир
Эс Эль Групп
ТРЦ Вэйпарк
BREAD & BUTTER
m-commerce
Honeywell
Энзо Капобьянко
кредитные карты
Ситибанк
Lada Granta
Samsung Galaxy
Toyota Mirai
ювелирные магазины
финансовые пирамиды
КамАЗ
контроль
Dockers
легализация
Джек Ма
управление персоналом
Верофарм
Aston Martin
Тим Кук
интернет-торговля
Retail's Big Show
Explay
Яндекс.Деньги
Visa Qiwi Wallet
ИНВИТРО
Алишер Усманов
стилус
рост продаж
кофе
чай
PONY EXPRESS
рынок логистики
ЕЭК
Street Beat
Prenatal Milano
Юникредит банк
онлайн-сделки
Молоко Бурятии
Бурятия
ТРК "Проспект"
Procter & Gamble
петиция
РСП
Услуги связи
бойкот российских товаров
импортозамещение
Mexx
банкротство
Melon Fashion Group
непродовольственные товары
вино
Нью-Йорк
Duty Free
Gebruder Heinemann
закрытие бизнеса
Gfk
программа утилизации
Lada Largus
умные часы
YotaPhone
Стив Возняк
уход с рынка
истории знаменитых магазинов
PPG Industies
международный рынок
Google Play
Apple Store
Mail.Ru Group
Porsche
Porshe
Tesla
Windows Phone
iOS
Марокко
растительная продукция
экономические игры
CRM
Альянс
сеть ресторанов
Александр Лукашенко
валютный коридор
Telegram
iTunes
iPod
Viola
МАРКЕТ
Славянка
Orkla
онлайн-торговля
ЕАЭС
валютные операции
Южный поток
Мистрали
американский рынок
уголовное дело
дефекты
Isuzu Ascender
Saab 9-7X
GMC Envoy
Chevrolet Trailblazer
Buick Lacrosse
интернет-агрегаторы
Inventive Retail Group
ФБК
Союзмолоко
взлом
номинации
Премия рунета-2014
онлайн-ритейлер
заморозка цен
поставщики
Cartier
повышенный спрос
люкс и премиум
служба доставки
каталоги
Международная ярмарка интеллектуальной литературы Non/fiction
обыск
прожиточный минимум
пособие по безработице
Сергей Лавров
Быстроном
ТЦ БыстроМолл
Покровский пассаж (Екб)
PR Trend
Кирилл Гасилин
Ли-Лу
Kira Plastinina
ТЦ ЦУМ (Йошкар-Ола)
MTG Germany
Project Line
PROfashion Awards 2014
eToro
Ping An Insurance Group
SBT Venture Capital
гирлянда
Geely
Glance
Буду Мамой
ФАМИЛИЯ
Fashion Retail & Distribution 2014
GetTaxi
GetTazi
e-commerce
Online Retail Russia 2014
сетевой рынок
прекращение производства
iPhone 5S
Новая Москва
STEP
Мягкофф
спецобъекты
розничные сети
Burger King
Шоколадница
мировой рынок
Geely Motors
GC-7
покупатели
QR-код
денежные операции
TechPay
SwiftPay
стартап
JLL
запрет на продажу
карта лояльности
дисконт
Магнит Семейный
Франсуа Олланд
гречка
федеральный бюджет
СпешиLove
Civic Type R
киберпонедельник
Деньги.Mail.ru
Roadster
Coup
MINI
Шокобокс
Сергей Шойгу
онлайн-сервис
денежные переводы
рецессия
законопроекты
Скартел
ТТР
Bosch
Online Market Intelligence
пиротехника
Fairlife
Galaxy S4
Galaxy S5
Мэйл.Ру Геймз
Одноклассники
iPhone 6 Plus
ФСН
Coldiretti
потери
Москва-Сити
Мастерславль
транзит
ГРЕКО
Минобороны
BMW
Huawei
5G
i-Series
i8
компьютеры
hi-tech
Lost Inc.
Lamania
Кубань
страшные слова финансистов
психология
розничная торговля
Primark
Nielsen
Kiva
госзакупки
стрит-ритейл
RRG
InSales
Data Insight
PayU
Nissan Juke
Nissan
Firefox
Mozilla
Taobao
Vocord FaceControl
Вокорд
Lada Kalina
Бухгалтерия
торговые сборы
ритейлер
Public Eye
курс рубля
интернет-ритейлеры
презентация
социальные карты
курение
патенты
Формула интернет-торговли
Общественная палата
Cadbury
планшет N1
Fitch
экспансия
Синкансэн
нефть
Vesta
Lada Priora
Дед Мороз
жалоба
интернет-услуги
TH Milk
Enter Vision
сокращение выпуска
Mirai
Toyota
iPhone 6
iPhone 7
Андрей Воробьев
Международный молочный форум
Silk Road
мясо птицы
Объединенные кондитеры
шоколад
Бабаевский
отзывы
DreamWorks Animation
TOPIX
Nikkei
Кэмерон
G20
НПФ Благосостояние
ОНЭКСИМ
новый завод
Volkswagen
SEAT
Ситилинк
Enter.ru
кино
Шоппинг
знак качества
дефицит
представительство
Stada
Siemens
General Motors
российский фондовый рынок
продовольственное эмбарго
пищевая соль
международные перелеты
авиабилеты
Росавиация
АТОР
интернет-компании
капитализация
Exxon Mobil Corp
Prime Air
Волконский
Наш хлеб
Fresh Food Russia 2014
драгоценности
искусство
Билл Гейтс
Sotheby's
Christie's
Министерство строительства РФ
ЖКХ
Henry Graves Supercomplication
Patek Philippe
Supremo Putin II
Смарт Лакшери Групп
Владимир Путин
Юнитоп
Alipay
интернет-площадки
KupiVIP
New Look
платежные системы
низкие цены
iPad
валютные спекуляции
Microsoft Lumia 535
Фонд Общественное мнение
уровень жизни
обмен валюты
снижение экспорта
ПК
Lokata
геолокация
ФТС
субсидии
индустриальные парки
технопарки
интернет-ритейлер
ЦБ РФ
LG
Xiaomi
IDC
выручка
рост спроса
валютный рынок
Trellas Enterprises Limited
долг
ОНЭСКИМ
валюты
термины
мотоциклы
Калашников
черный рынок
оружие
Чили
хэндмэйд
Demeter
Юрий Мильнер
расширение
Билайн
строительные товары
кибератака
утечка данных
Home Depot
новые гаджеты
Gunvor
предприниматели
продовольственный бизнес
CES
безопасность
ФСБ
Yota Devices
YotaPhone 2
Московская биржа
Flywheel Software
интернет-магазины
Couponbum.ru
законопроект
БАДы
вредная привычка
интернет-аптеки
электронный кошелек
Рапида
НОТА
Товары@Mail.ru
Price.ru
частный бизнес
Левада-Центр
кризис
объем продаж
еврозона
Windows 10
Windows 7
новая модель
рост курса
Lada Granta Liftback
Lada Granta GT
VK
Павел Дуров
бензин
ВШЭ
Fashion Consulting Group
Коммерсант
Ведомости
Subaru
изобретение
Кассовое оборудование
АЧС
Дмитрий Рогозин
вывеска
стихотворения
стоимость
российский рынок
Энди Рубин
Android
Тверская улица
бивалютная корзина
Union Pay
банковские системы
рождественский сезон
День благодарения
Black Friday
последствия
торговая недвижимость
нейминг
традиции
фото
россияне
население
благосостояние
бедность
нефтяной бизнес
ConocoPhillips
стратегия
Lenovo
Мостотрест
ТПС Недвижимость
Газпром бурение
Игорь Ротенберг
интернет-магазин
Qiwi
Иран
нефтегазовая компания
чистая прибыль
Shell
FCA
Ferrari
РАЭК
данные опроса
ФОМ
смешное
ручка
Росстат
продовольственная корзина
рост цен
Whitfield Bryson & Mason
MacBook
интернет-банк
Сбербанк Онлайн
Seppala
планшет
Xperia Z3
пошлины
партнерство
Россия и Китай
солнечные панели
Солар Системс
программы
Всемирный банк
Doing Business
Flickr
Pinterest
ученые
Фабрика Окон
30 октября 2014
27 октября 2014
16 октября 2014
Самое популярное
-
Акции на трех маркетплейсах: сравнение условий от эксперта
-
Мария Шалина, «Лента PRO»: «Отсутствие продукта — это стоп-лист в меню. Мы не имеем права подводить»
-
...и снова весна: как и почему «Лента» готовится к Пасхе целый год
-
Две России в рекламе: как меняется поведение аудитории в крупных городах и регионах в 2026 году
-
Больше никаких стратегий? Почему маркетинг в России теперь живет «в моменте»
Конкурс кейсов